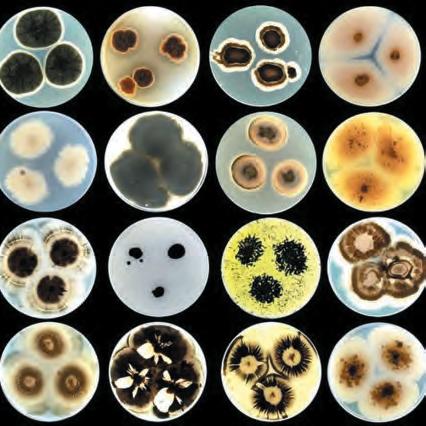

![]()



Multiphysics simulation helps in the development of innovative battery technology by providing insight into mechanisms that impact battery operation, safety and durability. The ability to run virtual experiments based on multiphysics models, from the detailed cell structure to battery pack scale, helps you make accurate predictions of real-world battery performance.
» comsol.com/feature/battery-design-innovation

03 Welcome
Chief executive Alice Bunn sets out IMechE’s response to the Industrial Strategy
40 The big interview
IMechE president Matt Garside wants to put trust front and centre during his one-year term
44 Next stop: the future
Rail travel has come a long way since Stephenson’s 1825 locomotive. What will the next 200 years bring?
50 Ready for launch
All things aviation were celebrated at the Paris Air Show. Here are five of this year’s stand-out projects
56 How to build a sun
We visited Iter in southern France to find out why the science of metrology is so crucial to nuclear fusion
64 Weird engineering
Can a car ever drive upside down? Yes, if
05 Opener
Why the slowdown of a key global ocean current could have huge repercussions for Europe’s climate
08 Buckle up
The first multi-adaptive seatbelt uses sensors to make car travel safer than ever
11 Five for the future
Meet the engineers and researchers who are coming up with groundbreaking innovations
13 Blueprint
Ahead of an upcoming IMechE report,we look atwhat engineers can do to improve accessibility on public transport
17 In the spotlight
Our series on IMechE members who are having a big impact profiles
Steve Fletcher
20 Ticket to ride IMechE’s Railway Challenge welcomed young engineers to tackle some of the rail industry’s toughest problems
23 Your voice
Readers have their say on key issues of the day
33 Transport automation
What challenges are raised by the increasing use of automation in transport?
Plus, an update on the IMechE headquarters
37 Driverless vehicles
The rise of autonomous cars could have a big impact on the powertrains of tomorrow
38 Artificial intelligence
NewAI-based simulation and modelling techniques are proving transformative
39 Communication
Why perfecting your interpersonal skills is important forworking in every industry


"We want to understand our products, understand our customers and focus on them. We don't really want to deal with the minutiae of servers and keeping the lights on, keeping the technology going."
Richard Hughes, Ecommerce & Marketing Mgr, Industrial Tool Company

Simplify with a single front and back end experience for retail and wholesale. Automate customer group management, and customise prices and discounts down to the unique SKU level.
Manufacturing buyers are different from other consumers, but they still expect modern buying experiences. Deliver an engaging and frictionless journey to gain a competitive advantage.

he UKgovernment’s publication of the Modern Industrial Strategymarks a commitment to shaping the nation’s economic future through innovation, resilience and inclusive growth. At the centre of thisvision is engineering as a driving force behind the success of keysectors from energyand infrastructure to advanced manufacturing and mobility. The challenges this strategyseeks to address are not unique to the UK. Howdowe equip peoplewith the right skills forthe future? Howdowe adopt newtechnologies at scale? Howdowe align growthwith environmental and social priorities?These are global conversations,within which engineering is a common thread.With eight highgrowth sectors identified – each demanding technical talent and agile, future-focused capabilities – engineering has neverbeen more relevant, essential orvalued.This new strategyrepresents a pivotal moment forthe profession and a recognition that engineering is the backbone of a prosperous, secure and sustainable society.
IMechE policy recommendations
Ourrecommendations are reflected across the strategy, including commitments to long-term and stable R&D funding and embedding systems thinking in innovation policy.The government’s pledge of £100m across three years forengineering skills in England is significant, and wewelcome the regional approach to skills andworkforce development. Equallyimportant is the emphasis on sector workforce strategies, simplifying the skills system and encouraging collaboration between industryand academia. As an Institution,we are calling fora National Engineering
is published by Think on behalf of the Institution of Mechanical Engineers.
PE, 65 Riding House Street, London W1W 7EH 020 3771 7200
EDITORIAL profeng@thinkpublishing.co.uk
Editor: Amit Katwala
Deputy editor: Joseph Flaig
Sub-editor: Rebecca Dyer
Group art director: Jes Stanfield
Executive director: Jackie Scully
Client engagement director: Kieran Paul

andTechnologyWorkforce Strategyto address theworker shortage and plan forfuture demand. Skills passports, increased support fortechnologyadoption and reforms tovisa pathways are also encouraging. Ourpresident, Matt Garside, points out that these measures must be met with close collaboration between government, employers and professional institutions like IMechE.
As an Institution,we areworking to realise this future. Our Learning and Development programme continues to evolve, designed to help engineers upskill and adapt.Thisyear alone,we’ve launched 14 newcourses,with a strong focus on the energytransition and heating and cooling systems. Our FocusWeeks, introduced in June, have brought engineers togetherthrough themedwebinarseries on critical areas of engineering practice.These free, accessible sessions provide opportunities formembers at everystage to learn from experts and peers.Two moreweeks are scheduled thisyear. We also continue to support early-careerengineers through ourstudent competitions, attracting teams from around the world, andyoung memberengagement initiatives.
Looking ahead,we’re excited about ourAdvancing Automotive Engineering Conference this October, a flagship event to explore trends and technologies spanning propulsion systems, emissions reduction, thermal management andvehicle dynamics. Ultimately, this is a moment forengineering to lead –with confidence, creativity and impact.The Modern Industrial Strategyprovides the opportunity. It’s up to all of us – engineers, educators, employers and institutions – to help build the future.
ADVERTISING 020 3771 7232
Commercial director: Michael Coulsey michael.coulsey@thinkpublishing.co.uk
Group commercial manager: Matt Hall matt.hall@thinkpublishing.co.uk
Senior commercial partnerships manager: Chris Barnard chris.barnard@thinkpublishing.co.uk
Commercial partnerships manager: Leanne Rowley leanne.rowley@thinkpublishing.co.uk
Copyright: Think Publishing 2025
SUBSCRIPTIONS
For address changes, phone 01952 214050 or email subscriptions@imeche.org
ABOUT IMECHE
The Institution of Mechanical Engineers is the professional body overseeing the qualification and development of mechanical engineers. It has 115,000 members in 140 countries.
Visit imeche.org for more information about membership and its benefits, or email membership@imeche.org.uk

@ProfEng tinyurl.com/PEmagazine


Views expressed in Professional Engineering are not necessarily those of the Institution or its publishers.
Chief executive: Dr Alice Bunn OBE FIMechE
President: Matt Garside CEng FIMechE MIET
IMechE is a registered charity in England and Wales number 206882

400+

A crucial global ocean current could soon stop, throwing the world into climate chaos. Can engineers adapt in time?
The picture for climate change is clear, set out in thousands of papers: temperatures will continue to rise for the next few decades; heatwaves, droughts and wildfires will be harsher and more frequent; rising seas will lap ever higher; and millions will be forced from their homes as crops fail and water runs out. At the regional level, however, the picture is fuzzier. Significant uncertainties remain around how certain meteorological systems will change – and what happens will shape the lives of billions.
The slowdown of ocean currents associated with the Atlantic Meridional Overturning Circulation (Amoc) is one such scenario, with significant repercussions for the UK, as well as elsewhere in Europe,
Africa and North America. The conveyor belt-like system of ocean currents carries warm water from the tropics northwards, causing milder winters for the UK compared with other countries at that latitude. Input of cold water from melting ice plays a key role – but as that melt increases, it is expected to weaken the system, and some researchers fear it could stop entirely.
The risk of such a change is still being studied. A Naturepaper by scientists from the Met Office and the University of Exeter found that the Amoc is unlikely to collapse over the next 75 years but “very likely” to weaken. A reduction might offset some greenhouse gases for Western Europe, but a shutdown would have extreme consequences.
75
years is the time period in which the Atlantic Meridional Overturning
Circulation is ‘very likely’ to weaken -
Changes to Amoc currents would have “profound implications for the outcome of our current adaptation and resilience-building strategies”, according to organisers at a recent IMechE event. Focusing on the Amoc slowdown, the 20 May webinar gathered experts to look

Electric vehicle batteries running too hot?
jbj Techniques have the answer. We can take your EV battery cooling requirement and turn it into a reality. Complete autonomous systems that can be used in conjunction with the vehicle air conditioning circuit. Power saving fan drives to reduce the draw on the EV battery pack. We can take your cooling requirements from concept through to the finished package.
Hydraulic system running too hot?
jbj Techniques have the answer. In line coolers or offline coolers available from our extensive range.
Need to cool your diesel or petrol engine, intercooler or gearbox oil?
jbj Techniques have the answer. For machine manufacturers requiring improved performance or combined cooling of multiple media in a compact design or different cooler area footprint.
Have a hydraulically driven cooling fan requirement?
jbj Techniques have the answer. Proportional fan drive systems having CAN Bus compatibility.
ATEX certified coolers - stainless steel coolers - coolers to CSM protection?
Yes, we have the answer.
Contact jbj Techniques Limited for carefully considered, excellently designed, cooling requirements.
jbj Techniques Ltd in partnership with IRA Engineering are pleased to announce an exciting new addition to their product portfolio. This new addition being the IRA Engineering, Italian manufactured, range of air blast coolers.
The range of air blast coolers is extensive, consisting of the RAL, aluminium, series of inline coolers, having a heat dissipation range of 1.6 kW to 200 kW (based on a aT of 40°C) and an oil flow capacity of 5 to 800 1pm.
at potential changes and assess physical impacts to the built environment. As with other aspects of adaptation, there will be a big role for engineers – and preparation needs to start as soon as possible.
Conventional scenarios assume a gradual increase in greenhouse gas concentrations and a gradual response from the climate system, according to Professor Nigel Arnell, climate science specialist at the University of Reading. But, he asked, “What if something weird happens?”
‘Weird’ changes
One of those “weird” changes could be an Amoc slowdown – and the effects could lead to a “step change”, Arnell said. He set out a scenario for South East England if the circulation switched off in 2030, based on experiments by the University of Exeter and Met Office.
“By 2050, temperatures are about six degrees cooler than they would have been otherwise, and then gradually increasing again, slowly, as the greenhouse effect continues to kick in. That’s quite a substantial change; we’re looking at temperatures three to four degrees below what we’re currently experiencing,” he said. “That will be well outside the range of human experience, and this is on average –around that we would get extremes and some ‘mild’ winters. But a mild winter would be really cold. We would likely see slightly less rainfall in winter and a lot less in summer… and we would expect a higher sea level as the Amoc switches off.”
Changes could be compounded by the collapse of the ‘subpolar gyre’, he warned, another ocean circulation that could, if switched off, lower temperatures by about 2ºC.

However, we do not know how close we are to the threshold for Amoc collapse, Arnell said, so the warning time could vary massively. “It’s not going to happen overnight, so we don’t need to worry about a TheDayAfterTomorrowscenario – we may get 25 years warning, it may be 10 years, it may be 40.”
Such uncertainty only increases the tension between preparing for different scenarios. “That’s an awful lot of challenging changes to deal with,” said Dr Tim Fox, chair of IMechE’s working group on climate change adaptation. “The built environment, physical infrastructure and other engineered systems will be subjected to environmental conditions for which they have not been designed – or indeed adapted.”
Engineers in Northern Europe should focus on developing “no-regrets” technologies, he told ProfessionalEngineering, which work in extreme heat and cold, and during both flooding and drought. “We must also concentrate on developing innovative solutions that futureproof infrastructure at the point of construction by enabling cost-effective changes.”
Engineering standards also play an important role in adaptation but
2050 could see temperatures in South East England six degrees cooler, according to one study
2ºC is the amount that temperatures could decrease by if the subpolar gyre collapses
so far have not considered potential “tipping points”, said Professor John Dora, director at consultancy Climate Sense. That is beginning to change, with standards including the adaptation framework of ISO 14090 being revised. ‘Adaptation pathways’ can provide flexibility for dealing with uncertainties, Fox added. The BS 8631:2021 standard, for example, provides “a full description together with the methodology,” he said.
However, with net zero efforts threatened by populist politics, how can we ensure adaptation is taken seriously? One of the best ways is highlighting the risks to clients’ business operations – and profits and shareholder value, said Fox. “It is crucial that we communicate with clients in a language they can relate to, focusing on value propositions, benefits to be accrued, co-benefits to be exploited, timescales for action and likely costs of inaction.
“Through taking this opportunity, our profession can help to ensure that adaptation is not abandoned in the decades to come.”



Above and left: The multi-adaptive safety belt can utilise data from different sensors positioned around a vehicle

The humble seatbelt just got an upgrade. This is the world’s first multiadaptive safety belt, designed to adapt to both traffic variations and the person wearing it in real time. It draws on a suite of sensors around the car to adjust the tension in the belt and reduce the risk of serious injury. For example, larger occupants in high-speed crashes might get a higher belt load to reduce the risk of head injuries, while smaller people in milder crashes might get a lower one to reduce the chance of rib fractures. The belt will debut in the electric Volvo EX60 in 2026. Here you can see an exploded view of the various components of the system, which was fine-tuned by Volvo engineers using a database of more than 80,000 real-life accidents.

CEJN eSafe 320 couplings offer high flow with a low-pressure drop, enhancing tool performance for increased productivity. Their innovative patented design vents downstream pressure before disconnection, effectively eliminating hose whip and reducing noise.
They also require low connection force and have a compact, easy-grip design that can be operated with one hand, making them quick and easy to use.
CEJN eSafe is the ultimate high-performance safety coupling with unparalleled durability for long-term use.
ventedsafety- onehandoperation - stainlesssteel- ISO4414
FIVE FOR THE FUTURE
Meet the scientists and researchers improving the world through engineering. For more, head to imeche.org/news



MIT engineers have developed an atmospheric water harvester that can pull moisture from even the driest air without the need for power. The device is a black, window-sized panel made from a water-absorbent hydrogel coating in a cooling layer. The researchers say the technology could be used to passively supply a house with drinking water.
can control live beetles with video game controllers thanks to a removable backpack that steers them in the desired direction. They hope the technology could be used for search and rescue.
OVERGROUND
UNDERGROUND

01 05
Researchers at the University of Southern California have created miniature flexible electrical stimulators that can be secured to the spine and triggered with ultrasound to reduce the symptoms of chronic pain without the need for a bulky battery.
04 03
Engineers have designed ‘living tattoos’ for buildings that could monitor pollution and reduce heat stress. The Remedy project, a collaboration between several European research institutes, is developing ink that contains microorganisms with various properties that can be applied to buildings with an inkjet printer.
Tube trains in London will run on solar power as part of a deal between EDF and Transport for London. One fifth of the operator’s output will come from a new solar farm in Essex as it strives to use 100% renewable energy by 2030.


Discover how Advanced Engineering 2025 is celebrating the Year of Rail, spotlighting innovation, hydrogen and cross-sector collaboration
Q: Why has Advanced Engineering chosen to spotlight rail for 2025?
A: Rail is at a pivotal moment. As the sector faces rising pressures – from climate resilience and decarbonisation to ageing infrastructure and digital transformation – it’s clear that the future of rail depends on fresh thinking.
Advanced Engineering is positioned to support that shift. By bringing together innovation from aerospace, automotive, energy and more, the show provides a space where the rail industry can discover new materials, smarter systems and proven technologies that can be adapted to meet its own challenges.
Q: What can visitors expect from the rail presence at future shows?
A: Advanced Engineering will continue to show how the rail industry is breaking out of silos and embracing cross-sector innovation. Visitors can expect a focus on emerging technologies, from composites and lightweight materials to AI, intelligent monitoring and climate-adaptive design, all aimed at building a safer, more efficient and sustainable rail network.
There’ll also be growing attention on the need to rethink long-standing standards that can slow innovation. As the sector looks to adopt solutions already proven in aerospace, automotive and energy, the conversation is shifting from “can we?” to “how soon?”
Q: How is the rail industry collaborating with other sectors at the show?
A: Today’s rail operators and suppliers are working closely with composites manufacturers to reduce carriage weight, consulting with aerospace engineers on systems design and looking to the energy sector for hydrogen storage and transport solutions.
For instance, rail engineers also collaborate daily with civil, electrical and mechanical engineers to ensure the smooth, safe and sustainable operation of railway systems. The rail content at the show has very much been designed with these overlaps in mind –to help spark collaboration and get all these people in one room together for meaningful communication.
Q: Hydrogen is a hot topic. How is it relevant to rail at the show?
A: At this year’s show, you’ll find exhibitors and speakers tackling these issues from a rail perspective, covering everything from modular storage and pressure vessels to safety standards and

















system integration. It’s a great chance to see how hydrogen tech developed for automotive and aerospace is now being adapted for rail, helping to drive the sector towards a cleaner future.
Q: Any final thoughts for rail professionals considering attending?
A: Absolutely – if you work in rail or want to get into the sector, you can’t miss this year’s event. Whether you’re an engineer, buyer, policymaker or innovator, Advanced Engineering 2025 is a chance to step outside your usual silo and connect with adjacent sectors doing incredible things in materials, systems and sustainability.

We’re putting rail front and centre – not just the big-picture challenges like decarbonisation and modernising infrastructure, but also the real technical advances driving progress. Think highspeed rolling stock, smarter signalling, predictive maintenance using AI and breakthroughs in power and propulsion. You’ll leave with practical insights and new contacts to keep momentum going. LEARN MORE

Ahead of a new IMechE report due later this year, we look at some of the challenges faced by engineers in trying to make mass transit more accessible
Anyone who’s tried to cross a city in a wheelchair or while pushing a pram will be painfully aware of the shortfalls of the UK’s public transport system when it comes to inclusivity. Research from the National Centre for Accessible Transport found that 79% of disabled people travel less often and 84% experience longer journey times due to barriers like cluttered pavements, a lack of step-free access and poor staff assistance. Outside of London, a lack of connectivity between transport modes means many journeys are impossible to complete on public transport – even for non-disabled people.
Isolation and exclusion
This has a huge impact on the wellbeing of disabled people, reducing access to work, health and leisure opportunities. Studies have found that the difficulty of accessing transport contributes to the fact disabled people have lower employment rates – 53.1% in the second quarter of 2024, compared with 81.6% for nondisabled people, according to official figures. Lack of available transport worsens social isolation, stress and anxiety, and creates a cycle of exclusion and inequality. But fixing these challenges isn’t easy. The UK’s transport network is a complex web of different operators: a single city may have

multiple bus companies and train or tram networks, governed by different regulations. Infrastructure upgrades provide opportunities to improve accessibility from the design stage, when it is easier and cheaper than retrofitting old kit and crumbling stations.
In Belfast, the £340m Grand Central Station project includes accessible features such as ticket machines with height-adjustable screens, help in sign language and a sensory nook respite area for neurodivergent people.
In England, Merseyrail’s new fleet of trains have been praised for their automatic sliding step that opens to meet the platform edge for unaided level boarding, as well as wider aisles and a continuous carriage, making it easier to move around.
to improve railway accessibility, but it only applies to specific changes to create accessible routes to or between train platforms. It doesn’t ensure level boarding when a train has pulled into the station.
Competing goals
Tension also arises with net zero goals, for example a move towards the use of e-bikes and e-scooters has stirred controversy due to them blocking pavements.
79% of disabled people travel less often because of public transport barriers
For engineers, though, improving the status quo requires a number of considerations. The first is the need to interface with existing infrastructure – our 200-yearold rail network is not easy to make quick changes to, and any significant work might require closing stations temporarily, thereby reducing accessibility in that area in the short term. Funding is also limited: the government’s Access for All scheme has been running since 2006 to try
However, engineers have a key role to play in helping people travel comfortably and navigate our multimodal network. Plenty can be done to harness this expertise, and the Institution’s policy team is working with expert members from the Automobile, Railway and Manufacturing Industries Divisions to find solutions. An IMechE report on inclusive transport, to be published in autumn, will also make a number of recommendations for improving accessibility on public transport.
Head to imeche.org/policy-andpress/reports to read the latest policy reports from IMechE, including the upcoming report on inclusive transport



IMechE member Steve Fletcher is exploring ways to keep the magic of iconic cars alive in the electric, selfdriving era. By Alex
Eliseev
The day Lotus launched its “intoxicating” Emira sports car – a “track beast” with a price tag north of £80,000 – few people were thinking about its windscreen wipers. But Steve Fletcher was. He was thinking about them a lot.
The engineer joined Lotus when the Emira was nothing more than an idea, waiting to become a design. With his team, Fletcher worked on the car during the Covid years, emerging with the “world’s fastest four-cylinder sports car”, which screams around corners, leaving echoes of Lotus lore in its wake.
Fletcher was there on launch day, in the summer of 2021. He, and everyone else at Lotus, had hoped for clear skies and sunshine. Instead, they got rain. Bucketloads.
“There was a torrential thunderstorm in Norfolk. It was chucking it down,” he remembers. “The car was still a prototype. It hadn’t done many development miles. It had never really been out in the rain. It came out, with (Lotus’) Gav Kershaw driving it, windscreen wipers at full pelt, working properly. I was like ‘Yes!’”
To understand his excitement, one has to travel to the streets of Coventry, where he grew up “in

the shadow of” Jaguar’s factory, and back to the 1980s and 90s, when Ferrari F40 and Porsche 959 posters adorned his bedroom walls.
Always having a go
One of four children, Fletcher grew up in a busy home near the Browns Lane plant (which Jaguar no longer uses). His mother worked as a nurse and his dad as a tradesman.
Helping his dad fix cars, Fletcher adopted an “I’ll have a go” attitude, which spilled over into dismantling stopwatches, clocks and televisions – with mixed success.
“Everyone I knew, their dads worked at the Jag factory or some other car plant,” Fletcher explains. “I was super-inquisitive about anything mechanical. For a while, I broke everything. Then, as I grew

The ELESA standard in your favorite COLOUR
The
up, I started to break fewer and fewer things.”
With guidance from a physics teacher he remembers fondly, he decided to study mechanical engineering at the University of Leeds. He loved physics, with its balance of logical mathematics and abstract weirdness (like quantum mechanics) – but was steered towards mechanical engineering as ‘applied physics’. He was also a keen musician, playing bass guitar for a covers band that was filling out some big venues and had a residency at a local bar.
From musician to conductor
With his engineering degree, Fletcher landed a spot on Jaguar’s graduate programme. He’d done a lot of FEA (finite element analysis) simulation during his studies, which came in handy at Jaguar.
He worked on projects like the XF model, analysing side and rear crash simulation models and feeding them into the design.
“This was absolutely foundational. I worked on some amazing projects,” Fletcher says. “Our analysis drove a lot of the design.”
After about six years, Fletcher joined Tata Motors, which coincidentally landed up buying Jaguar. He started travelling to India, to train and develop teams. He also helped draw up a roadmap for the company to break into global markets.
In the years that followed, Fletcher worked at a consulting firm, popped back to spend another year at Tata, jumped in for a thrilling ride at Lotus and tried out a few start-ups. He grew from an engineer solving problems into a business leader, managing teams and designing organisational structures.
Fletcher studied further and was exposed to global client work and business development. Or, as he likes to frame it, he went from


being a musician in the orchestra to a conductor, who had learned to be comfortable with the fact that he can’t play every instrument.
Earlier this year, Fletcher, an IMechE member, joined DRVN Automotive Group as technical director. It was another job that “scared the hell out of my wife”, he jokes. That’s because it was an adventure with a young company out to capture the illusive magic of “peak analogue” – restoring or replicating classic cars from bygone eras.
DRVN is a low-volume business, associated with a handful of big motoring brands, from Ferrari to Ford. The company is designing its own “reimagined” classics
‘The hardest decision I ever made was to leave Jaguar. But I didn’t want to be the guy riding it out until my pension’
– which are top secret at the moment – but most of its efforts go into modifying or recreating heritage cars (like the Ford Escort RS Mk1), driving them into the 21st century. This includes using new, lightweight composite materials or boosting the performance of a powertrain. There’s also a big focus on optimising parts and improving the driver’s experience.
While DRVN is exploring alternate fuel technologies to lower emissions, it’s not turning internal
combustion cars into electric vehicles. Fletcher says their clients are after that “visceral sensation” that came before today’s “iPhone type of vehicles”.
He is enjoying the new challenge and loves finding simple ways to understand incredibly complex engineering problems – like how to improve a set of windscreen wipers from the 1960s.
Don’t be a passenger
Fletcher still plays bass, although not as much nowadays, and has two children. He also likes to run and conquered the London marathon a couple of years ago.
To engineers just setting out on their journeys, his message is all about remaining firmly in the driver’s seat.
“Own your career,” he says. “The hardest decision I ever made was to leave Jaguar. But I didn’t want to be the guy riding it out until my pension.
“A lot of graduate engineers are looking for a business to help them. Flip this around. Make your own decisions. And ask questions. Even the dumb ones. You’ll usually find there are five other people in the room who don’t know the answer.”
To nominate an IMechE member making a difference, email profeng@ thinkpublishing.co.uk
Young engineers got the full rail industry experience at IMechE’s Railway Challenge. By Joseph
Flaig
Teams of aspiring engineers tackled some of the rail industry’s most pressing challenges in June, demonstrating new ways to optimise passenger comfort, regenerative braking and auto-coupling with bespoke locomotives. Designed to show the interesting and rewarding careers available in the sector, the IMechE Railway Division’s annual Railway Challenge returned to the Stapleford Miniature Railway, near Melton Mowbray in Leicestershire, from 26-29 June.
The event’s 14th year featured 12 full teams, including university students as well as apprentices and graduates already working in industry. Eight groups brought locomotives to the competition, which featured both static and dynamic challenges.
The joint team from Network Rail and Colas Rail came out on top overall, with victories in the energy storage, auto-coupler and business case challenges. Two of the three
international groups made up the rest of the podium, with Germany’s Team Eagle from the Nürnberg Institute of Technology in second and FH Aachen’s FH2Rail in third.
Among the new additions to the competition was the ride-on challenge, meaning teams could design their locomotives to accommodate drivers for the first time, instead of requiring them to sit on the first passenger carriage. Four took the opportunity, with Poznan University of Technology winning that component.
Smaller,
Set in gentle rural surroundings, the 10¼ inch (260mm) gauge railway at Stapleford Park informed some of the challenges.
The markers for the energy storage challenge, for example, were on a flat stretch of track next to the lake, which buzzed with dragonflies and butterflies in the hot June sun. A sloping section was used for the traction challenge,

where the teams’ locomotives had to accelerate while pulling two coaches.
“They learn then that it’s not just about having a lot of power, because the wheels could slip,” explained Simon Iwnicki, chair of the challenge’s organising committee.

Other track events included the passenger comfort challenge, which measured acceleration, and the auto-coupler challenge, automation of which is a focus for the industry. In the maintainability challenge, teams had to remove a powered wheelset from the locomotive as quickly as possible, then put them back and start moving again.
“We’re throwing them real-life problems… to see what sort of novel ideas they can come up with,” said Andrew Skinner, immediate past-chair of the division. “There’s a lot of established solutions, but are there smaller, lighter ones for the same problem?… Weight is a key thing for us.”
The track also featured a new turntable, which helped prevent delays and should enable the competition to more than double capacity in future.


Taking part in the competition gives aspiring engineers solid technical experience, said Alice Callaghan, a competitor in Ricardo Rail’s winning 2018 team and now a challenge judge. “It might be their first proper experience of the railway – you might not know what a bogie is before you do this, but you’ll definitely know by the end of it,” she said.
‘Hands-on experience’
She continued: “It’s understanding the set-up, understanding signalling, understanding how it’s happening, for a full appreciation of the railway. That’s really important – a lot of the time you don’t get the opportunity to be really hands on, and having that hands-on experience is just brilliant.”
The industry as a whole benefits from the challenge, she added –a previous Birmingham team had a hydrogen locomotive, for example, which fed into work on the Hydroflex mainline locomotive with Porterbrook.
“They’re all quite sophisticated machines,” said Iwnicki. “We provide a specification and a set of rules; they’re not very detailed documents. We want them to be
as free as they want to be in the way they design them, obviously within limits: they have to run on our track and fit through the tunnel, and be safe to operate.
“But they can choose any form of motor power, any form of control… We try to mimic the challenges that are real in the railway industry.”
The event also offers great opportunities for networking and discussions with senior employees from major rail and transport organisations, the organisers said, such as chief judge Bill Reeve, director of rail for Transport Scotland. Lots of the students that have taken part are now in senior positions in railway companies, Iwnicki added.
Aspiring engineers at the event learn from each other as well as senior colleagues, said Callaghan. Locomotives are inspected for potential upgrades for next year, and teams get bonuses for going out of their way to be helpful.
“A team might lend a piece of equipment, or they might have a spare part that they can share with others,” Callaghan said. “It’s just
‘You might not know what a bogie is
before you do this challenge, but you’ll definitely know by the end of
it’
really friendly; you go around and you see what everyone else is doing and you learn. That’s the way it works – and that’s the way the railway is as well.”
As well as 12 full teams, five entry-level teams were also present, benefiting from the open sharing of knowledge. One group of students from Monash University in Melbourne, Australia, attended, bringing a virtual design with the intention of returning in 2026.
“The teams are really nice and they were very willing to answer our questions. So, just by being here, we already have a much better idea of how we should redesign our locomotive,” said Patrick McCarthy, chief technology officer of the Monash Railway Express team at the university. “We’re looking to get a minimal viable product – and we have to make it quickly, because it’ll take three months to ship overseas to the UK.”
Travelling all that way – and planning to transport a locomotive the same long distance – reveals how valuable the event is. “Australia has a really big industry in rail, and currently there’s pretty much only a few courses,” McCarthy said.
“The only way that people learn is by getting a job in a rail company and learning from there. So what we’re trying to provide for Australians is that stepping stone into the rail industry, which currently just doesn’t really exist.”
For more information on how to enter IMechE competitions and challenges, visit imeche.org/ events/challenges

Got something to share with the IMechE community? Write to us at profeng@thinkpublishing.co.uk, using the subject line ‘Your Voice’
In his article ‘Could better batteries electrify rail travel?’ (issue one of 2025), Chris Stokel-Walker repeats the much-quoted figure of only 38% of our rail network being electrified. But this is measuring in route-miles, not by usage. Given the high capital cost of electrification, it is inevitable that the busiest lines are electrified first. If measured in passenger-miles (i.e. usage), that figure jumps to nearer 70%. Similarly, our motorways are a modest percentage of the road network in length, but carry a much larger share of total traffic.
The Merseyrail extension cited, using batteries, was absurd: just one mile of relatively cheap third rail (not overhead) electrification

was avoided, at the Office of Road and Rail’s insistence, for unnecessary complexity and cost on the trains that are proving troublesome. Where our rail network desperately needs electrification is in in-fill schemes, notably for long-distance freight traffic, e.g. the short branch lines to the ports at Felixstowe and London Gateway, but also for passenger services such as to Uckfield in Sussex – currently diesel in otherwise electric


I have been a membership adviser for a number of years, focusing on member to fellow upgrades. My role is to review applications against the defined competencies and make a recommendation to the Professional Review Committee as to whether the applicant should be upgraded to FIMechE. It’s been a fascinating, enjoyable and rewarding experience learning how others are progressing their professional careers in the wonderful and diverse world of engineering.
However, assessors return a significant number of applications as the information and evidence provided is incomplete. A reasonable conclusion is that the sponsors have not carried out a critical review of the application and worked with the applicant to ensure it meets the criteria. At least one sponsor should be a fellow of IMechE or another professional institution registered with the Engineering Council, so should be familiar with the process and its requirements. The guidance notes state: “You should discuss your application in detail with your sponsors to ensure they agree with the information you have provided. They are signing the form to indicate that they believe you are suitable for consideration as a fellow of the Institution of Mechanical Engineers.” Applicants, pick your sponsor with care and use them as your mentor to help you present an application that will be successful. Sponsors, it’s a privilege and a responsibility to be asked to sponsor an application, so do take time to review the application and advise as necessary.
Applicants, pick your sponsor with care and use them as your mentor to help you present an application that will be successful
Wishing future applicants at any grade every success with their applications. Bob Hayes
territory. Scotland has led the way with a rolling programme of electrification, which keeps construction teams together and progressively reduces both capital and operating costs. David Odling
The International Energy Agency’s inability to accurately predict deployment of global renewables (‘The hydrogen revolution’ in issue
one of 2025) is quite well known. It is also known for a bias towards traditional energy generation methods. For the sake of balance, could ProfessionalEngineering compare its predictions for hydrogen’s annual demand in 2050 to another source?
The brilliant Auke Hoekstra of Eindhoven University has compared predicted solar deployment against actual for several IEA annual growth reports.
Joshua Knight

Patron: His Majesty King Charles III

Supporting members and STEM projects worldwide
DIVERSE people need diverse support. That's why, at Support Network, we tailor our responses to meet individual circumstances.
We're the personal, practical, and emotional support organisation for IMechE members and their families worldwide. All our support is free and confidential.
We know that no two situations are the same. Life brings various challenges: health issues, financial
difficulties, or unexpected changes like unemployment or bereavement. We assist in all these areas and more. Our small paid team works alongside volunteers drawn from the IMechE membership, who help with visits and initial assessments, and also contribute strategically as Trustees.
Over the last five years, our Foundation Funding work has given support to STEM projects in the overlapping areas of international development. education and engineering innovation. We can reach many more people in this way.
In this Annual Review, you'll find examples of our foundation work
plus comments from members we've helped. It presents performance statistics and a financial breakdown, including member donations, which are gratefully received. Finally, you'll read the perspectives of some of our Trustees.
In 2025-2026, we'll conduct a member survey and focus groups seeking your feedback and suggestions for further development. In the meantime, we hope you enjoy reading about our work and what Support Network provides for the wider IMechE community.
ANNI BROADHEAD, Chief Executive Officer, Support Network
1111
I am profoundly grateful for the unwavering support, encouragement, and empathy demonstrated by the Support Network team.

I am writing to express my heartfelt gratitude for this generous financial grant. Words cannot adequately convey the depth of my appreciation for the help provided by your entire Support Network Team and the esteemed Trustees. Receiving this grant is a tremendous relief and will give me much-needed breathing space during such a challenging time in my life.
Beyond the financial assistance, I am profoundly grateful for the unwavering support. encouragement. and empathy demonstrated by your kind self, Maureen and Mrs Laura Clyne and the entire Support Network team. Your dedication to your work and compassion towards those you serve are evident in every interaction and gesture of kindness.
I also extend my sincere appreciation to the Trustees for their vision, guidance, and commitment to the mission of both the Support Network and IMechE as a whole. Your collective efforts ensure that individuals like myself are given the opportunity to overcome obstacles and pursue our goals with renewed hope and determination.
Thank you so much for your email -and for confirming the final payment. Ijust wanted to take a moment to sincerely thank both you and Maureen for all the support you've provided throughout this long journey. From the very beginning to the final stages, you've both been incredibly helpful and patient. and I genuinely couldn't have seen this through without your guidance and encouragement.
It hasn't been an easy time for me or my family. The disability adaptation construction work caused a lot of disruption -restless nights, constant dust. and plenty of complaints from the kids and my wife! But now that it's finally over, I think the whole family deserves a night out-and honestly, I wish I could bring you and Maureen along as well. You've both been right there with me every step of the way. You have helped me -helped us all, to stay actively living at home together.
£415,632
is the total grant support to members in 2024, of which £50,578 {12%) supported international members
I hope to one day be in a position to give back and support your organisation in achieving its goals.

Thank you very much for following up with us. My son had his test on Monday and the initial feedback from the assessor confirms our thoughts that he does indeed have a level of dyslexia. This now provides the tangible evidence for his EHC (Education, Health and Care) plan application to hopefully enable future Special Educational Needs support for him. We now have everything in place for the EHC plan application.
I can't emphasise how grateful my wife and I are for the IMechE support and your specific help with this; it has now given us the best chance of getting support in good time before secondary school transition. I'll check the payment arrives OK, but thanks to you and your team once again for some fantastic support.
I am writing to express my sincere gratitude for the Christmas hamper I received yesterday evening from Support Network. It was such a wonderful surprise and I am so grateful to be remembered at this time of year. Losing my partner so suddenly was difficult. Support Network has been invaluable to me, and I am truly thankful for all the help and support I have received.
Now that I have started my pension and am working on my projects, I hope to one day be in a position to give back and support your organisation in achieving its goals. Thank you again for your kindness and generosity. I wish you and everyone at Support Network aver happy festive period.
It has been a privilege and pleasure to work alongside the Sky is the Limit team and Support Network in Uganda, as together we are helping some of the most needy children and young people in Fort Portal via the school and linked farm project.
It was great to see the new farmhouse completed, irrigation system installed, and new crops developed to supply the school children with additional nutrition and regular meals. We look forward to the establishment of the new poultry shed and three-year development plan for the school, which will be transformational.
All of this has been made possible by the kind and generous donation of resources by Support Network and IMechE members, and we look forward to continuing the journey together over the coming years Thank you!
MATTHEW BAND
CEO Mondo Foundation

In countries outside of the UK where there is high demand, we now work directly with partner universities to support final-year mechanical engineering students in financial difficulty.
The universities help us to focus our support on those students who need it most. In 2024, we worked with seven universities in Nigeria and Malaysia, supporting 92 students. In 2025-26, we will expand this programme further, initially reaching out to all universities and countries where the IMechE has a student chapter. In 2025, we aim to work with universities in Angola, Ghana, India, Palestine, Pakistan, Papua New Guinea, and the West Indies.
LAURA CLYNE
Operations and Services Director, Support Network
Our Foundation Funding work enables Support Network to reach much further. We support STEMrelated projects on a global basis in education, international development and engineering innovation. This is a valuable extension of our core work. We now contribute to 14 of the 17 United Nations Sustainable Development Goals.
As a Support Network Caseworker I get much satisfaction in my role, supporting members 'in need.'
For example, receiving a simple email asking if we can help to find a new job role or a role after redundancy will result in a positive and holistic response: Yeswe can help with employment support. Do you need grant support too? Do
Currently casework involves helping members (or their families), administering grants towards neurodiversity support. e.g. autism, dyslexia, etc. I was surprised at the number of queries we received after recent marketing but am aware there could be many more to come.
Mental health issues are losing their stigma. While we had an increase in requests for professional counselling in 2024, there are even more people who might benefit from this support
-after all, 'a problem shared .. .'. Counselling can be a stand-alone service and the primary reason applicants contact us. However, part of my role involves assessing additional needs; for example, a financial grant application might indicate that counselling would also be appropriate. you qualify for a reduced subscription? Could you benefit from our other services? We always explore the member's situation in the round, as we can help in many ways, and applicants do not always realise that.
Money! The cost-of-living crisis has had a huge impact on many who might consider themselves well paid and who 'ought to be able to manage'. My role is largely dealing with financial applications, often referring to a debt specialist and in many cases awarding grants to assist with emergency needs (rent/mortgage/utility arrears). As a grant-giving charity, we are aware we have a diverse membership group with unique challenges and so adopt a 'no one size fits all' approach to our grantmaking processes.
So please contact us if you have a 'need' (something which is not always easily definable) as we cannot help without that initial enquiry or request. Making that first call (or more typically emailing) might be difficult but it is usually the hardest step, as we can work with you to improve your circumstances, both in the short and longer term. We're dedicated to helping IMechE members and their families, so do get in touch, as there is usually something that we can provide.
MAUREEN HAYES
Support & Casework Officer, Support Network

assistance included:
9 Newly Qualified grants to help with first steps in STEM careers
134 Student and Apprentice grants, awarded to international and UK-based mechanical engineering students
129 'Breathing space' grants to help members pay essential bills in times of transition or unanticipated circumstances
157 Fuel and extra Winter Warmth grants given to those on fixed incomes or households with disabled and/or vulnerable members
support included:
22 parenting support advice and/ or respite breaks for carers
121 counselling grants to help manage mental health difficulties or work through past traumas
131 in-person and online social visits, calls and on line contact made by our volunteers.
help included:
47 neurodiversity specialist support grants/programmes and/or initial diagnoses of autism, dyslexia orADHD
13 sleep support programmes provided to tackle the underlying causes of poor sleep
34 employment coaching and CV specialist referrals to help members get back into or start work
125 callers used the legal helpline and downloadable factsheets for advice on tax, probate and housing matters.
International project grants included:
1 bridge built in Rwanda to connect isolated communities and support local livelihoods
110 young people from disadvantaged backgrounds given opportunities to make new friends and engage in outdoor or STEM activities with Go Beyond
236 children attending school in Fort Portal, Uganda, given access to a science room for their lessons.
MARTIN BURROWS F/MechE
Career in pressure vessel design, manufacturing, oil and gas sector. IMechE Fellow since 2011.

WENDY GARNER Chartered Engineer
Former manufacturing engineer for Rolls-Royce and academic at Coventry University.
Having recently retired, I am keen to continue my links with engineering and especially to help the young engineers of the future. Working as a Trustee for the IMechE Support Network gives me the opportunity to use my engineering and academic experience to do this. I very much look forward to the year ahead and being part of the good work that the Support Network team delivers.
I enjoy volunteering as a Support Network Visitor because I find it interesting to listen to other engineers talk about their careers and have the opportunity to offer support when it is needed. I became a Trustee to help me understand how the Support Network operates and help where possible to contribute to its ongoing success.
MAJULA RAJAPPA Young Member Trustee
University can be a rough path to tread alone. Many of us have had to juggle financial worries, family obligations, and sometimes even the responsibility of caring for a loved one. As such, it can be lifechanging to receive support from any available channel. Support Network is one such source. Not only has Support Network helped me as a student and Newly Qualified beneficiary, but it also provided me with an amazing opportunity to give back.
When I started as a Young Member Trustee, I was the first Trustee to still be studying. I was therefore able to bring a unique perspective, drawing from my lived experience of being a student. I was able to speak about being part of an applicant group. My years on the Trustee board have been enlightening, as I have encountered diverse situations and perspectives. Engineers have challenges too!
I highly recommend young engineers to consider engaging with Support Network for an enriching experienceeither as a contributor or as a recipient.

or engineers with a passion for solving complex challenges and working on mission-critical technology, there’s never been a better time to take your career to new heights. At BAE Systems we’re recruiting to support cutting-edge radar products, and we want to hear from talented individuals at every stage of their professional journey.
BAE Systems provides some of the world’s most advanced, technologyled defence, aerospace and security solutions, helping customers stay ahead of evolving threats across land, sea, air, cyber and space. Cowes on the Isle of Wight acts as the central hub for radar innovation and collaboration, a unique site with industry-leading facilities. Our team and opportunities are also based in Portsmouth and Chelmsford.
We’re revolutionising radar capability and embarking on a once-in-a-generation portfolio refresh where we demonstrate and leverage innovative technology into a new product offering, supporting the UK’s campaign for Future Air Dominance and establishing leading capability with our customers across the globe.
ENGINEERING ROLES ACROSS DISCIPLINES
Our radar sector demands the expertise of engineers in disciplines including: l Mechanical Engineering – design and develop the physical structures and thermal systems that house and
protect advanced radar equipment.
l Systems Engineering – integrate complex subsystems into cohesive, high-performing solutions that meet the requirements of our clients.
l Electronic and Electrical Engineering – drive the development of signal processing, power systems and critical control electronics.
l Software Engineering – develop and optimise the real-time code that powers radar systems, from algorithm design to UI development.
l Integrated Logistics Support – ensure long-term maintainability and reliability of systems during their lifecycle.
l Systems Design Authorities – provide strategic oversight and technical leadership on all programmes.
l Project and Engineering Management – lead the delivery of exciting and complex projects and drive people development and career progression. No matter your speciality, you’ll work with multidisciplinary teams, leveraging stateof-the-art facilities and collaborating with the brightest minds in the industry.
CULTURE OF INCLUSION AND EXCELLENCE
Innovation thrives on diversity, and we are committed to building an inclusive workforce. We strongly encourage applications from individuals who are under-represented in engineering and technology, including women, people
Ready to dive into a new challenge? BAE Systems is hiring talented engineers across various disciplines
from ethnic minority backgrounds, individuals with disabilities and LGBTQ+ professionals. We also support veterans and reservists, recognising the unique skills and perspectives they bring.
MODERN WAYS OF WORKING
We understand that applicants want a healthy work-life balance and an environment that supports wellbeing. That’s why we embrace modern working practices that prioritise flexibility and autonomy without compromising on collaboration or performance.
Many radar roles are based on the Isle of Wight, home to our flagship radar site and a growing community of engineers and technologists. It’s an exciting place to live and work, with scenery and lifestyle to suit all. We offer competitive relocation packages and preferential rates on connections to the mainland.
READY TO TAKE THE NEXT STEP?
If you’re ready to make a real impact in radar technology and join a forwardthinking team that values innovation, inclusion and excellence, visit our careers page and join our Talent Community for opportunities, company news and invites to events and webinars.



IMechE is working to make sure AI is safely incorporated into autonomous systems, writes Robin Sarfas, the Institution’s engineering community impact manager
Automation is increasingly used in every mode of transport. Beyond vehicle control, AI is being applied to assist or replace human task elements in system design, maintenance and operation, and these challenges are fundamental to most human-centered systems being disrupted in this way.
IMechE is driving forward a programme, motivated by its 132nd president Carolyn Griffiths and co-sponsored by the Royal Academy of Engineering and the Parliamentary Advisory Council for Transport Safety, to establish better practices to safely integrate autonomous systems. During her time as chief
of the Rail Accident Investigation Branch, Griffiths saw her fair share of accidents caused by inadequate understanding and anticipation of human performance. She said: “We must step up our understanding of the range of human performance, how it can change over time or due to other factors, in an automated environment. We are overdue a systematic framework of protocols and principles that ensure we engage new understanding. Engineers must recognise that complex systems require people and technologies to work together, contributing to the performance of the systems
themselves, as well as the impact of system design on behaviour.”
To this end, Griffiths organised the 2024 Thomas Hawksley Lecture by Professor Sarah Sharples, chief scientific adviser at the Department for Transport. The feedback from this event confirmed that this is an area in need of more concerted attention from the engineering community, so Griffiths and Sharples convened a roundtable of 20 of the UK’s top experts to discuss these challenges, focused in four areas. What follows is a summary of each of these challenges and a high-level overview of the key takeaways.

‘AI is often intended to improve over time, so how do we regulate a technology that evolves after its efficacy has been assessed?’
1 How should the engineering design process change with the adoption of AI in transport?
The behaviour of autonomous and AI-enabled systems poses challenges due to the complexity of the systems themselves and their ability to evolve and learn, as well as their operation within a complex and highly variable system of systems. Operator performance will also fluctuate due to natural factors such as health, ageing and ambient conditions. Interactions between the driver, other vehicles, the environment and remote decisionmakers produce an effectively infinite set of circumstances for autonomous systems to process and react to. Iterative design is key to building up the capabilities of the systems to manage this complexity, with initially unforeseen interactions and circumstances emerging in testing. This more agile design process is not yet prevalent, but would provide designers with a wealth of additional data to be the basis of assurance of the system, which includes elements of AI.
A threshold must be agreed upon to define what is “safe enough”. That threshold will be different for different modes: there is a variation in degrees of freedom across transport modes.
Professor Roderick Muttram, who chaired the discussion, noted: “The improvements made in UK mainline rail mean that the last driver errorcaused fatality was at Ladbroke Grove in 1999, over 25 years ago. Any system for controlling trains must achieve a similar level of integrity.”
Realistically, an adoption of a threshold is likely to mean regulation will exclude some technology capabilities where there is less data for assurance from deployment, but this compromise is imperative to help build trust. Moreover, these considerations should feature in design and validation processes, defined as part of the regulated approvals process.
2 How do we develop a means of safety assurance for transport systems that incorporate AI?
Many AI technologies are intended to change and improve over time, learning through exposure to different experiences and circumstances. This presents a challenge for assurance and regulation: how do we regulate a technology that evolves after its efficacy has been assessed?
Machine learning and AI-enabled systems can self-learn from data
collected in operations, but this self-learning should be done in a controlled environment away from production, so it can be validated and verified before being deployed on vehicles in live environments. This need to conduct assurance will limit the rate of change for systems evolving and constrains some of the benefits of ‘continuously deployed AI’, but it is a necessary trade-off to make systems safer. There is also the question of transparency into both the algorithms at the heart of these systems and the performance of AI models within strict intellectual property frameworks. Safety can currently only be assured through an understanding of what is going on in the decisionmaking process. Yet the use of opaque technologies, which even their designers cannot understand, results in the so-called ‘fallacy of explainability’ i.e. the belief that humans can explain their decisions and therefore that it is possible for AI-based systems to produce equally compelling explanations.
A culture where manufacturers work with regulators, extending what is required by the legislation that established air, rail and marine investigation branches, will allow accidents and aberrant performance to be investigated without threatening intellectual property. This open collaboration is essential for safety.
3 How should training evolve to enable engineering and human factors professions to work effectively with AI?
As the technology underpinning safety-critical and safety-related systems evolves, so must the competencies of designers, operators and, to some extent, the public when it comes to products on the market. The obvious answer to this issue is that existing further and higher education courses must evolve with contemporary challenges in mind. There is agreement that teaching young engineers concepts of systems thinking, and generally making courses more interdisciplinary, is to
‘Our experience is that CPD must be grounded in practical issues that are relevant to the domain. We see real willingness to engage at the engineering level’
be desired. However, there is already great pressure on syllabi; there comes a point at which adding more content to undergraduate courses means dispensing with other material. It may take time to incorporate these principles into education, and the skills gap risks widening further, but there is an imperative for change to reflect the technology at large.
Much of the emphasis, at least in the short to medium term, must be placed on engineers’ continuing professional development (CPD) to upskill experienced engineers and meet the requirements for earlycareer professionals taking their first steps in industry. CPD cannot replace education as the process for embedding core competencies in engineers, but it can bridge a gap in workforce capability while technology becomes more widely prevalent, and ensures professionals can remain competent as technology evolves.
Professor John McDermid, director of the Centre for Assuring Autonomy at the University of York, had this to say: “Our experience is that CPD must be grounded in practical issues that are relevant to the domain, e.g. rail or maritime. We see real willingness to engage at the engineering level, but it is also important to provide CPD to policy and decision-makers.”
In the UK, a clear case must be made for regulators, the Engineering Council and professional engineering institutions to embed human factors into both education and CPD, and likewise human factors professionals must be equipped with a robust understanding of the design process.
4 What is needed to support multidisciplinary teams to maximise the impact of AI on transport safety, effectiveness and resilience?
The emphasis on interdisciplinary thinking must go beyond traditional branches of engineering to include
human factors. Incorporating human factors comprehension should be mandated and not ‘left to chance’. Professionals at the interface between engineering and human factors should have both specific understanding of how to identify and mitigate the risks, and how to capitalise on the opportunities of interaction and integration of human performance, automation and AI.
Frequently, human factors concerns are thought to be taken care of simply by the presence of a specialist, rather than being considered at each stage of the design process. There is a risk that businesses only see the true value of human factors when damage is done, either to their bottom line or after a serious accident. Instead, engineers must take responsibility for considering the principles of human factors throughout the design process –embracing human factors expertise rather than seeing it as a box to tick.
Emphasis must be placed on shared experiences and a common language within multidisciplinary teams to change the culture and enable the development of hybrid skillsets. Engineers throughout the value chain must buy into a set of principles underpinned by an all-encompassing appreciation of the relation between engineering, human factors and safety.
Work continues within this programme to define the problems described above and how they can be resolved. This roadmap will build on many sources of research and opinion that already exist and the expertise of those engaged in this workstream. What is clear already is that these challenges will not be overcome individually, in one mode of transport or in one discipline of engineering. Problems emerging for the deployment of new technology in a system of systems require the input of experts drawn from throughout those systems.
he Headquarters Programme aims to address the key challenges facing the Institution’s London HQ and ensure it continues to meet the needs of members, while supporting the Institution’s long-term purpose and strategy.
The programme is entering its next phase as the Trustee Board reviews a shortlist of options – a decision that will help shape the Institution’s future. A preferred option is expected to be selected in the coming weeks. This will be presented to members for approval via a two-week ballot, which will be launched following a hybrid special meeting. All members are encouraged to attend, and eligible members are urged to cast their vote and help shape the Institution’s future. The future of our headquarters is an important and complex decision. We are committed to a thorough, transparent process, and to making a choice that best serves the long-term interests of the Institution and our members. I would like to thank the Headquarters Sponsor Board, and IMechE colleagues and volunteers, past and present, whose commitment and expertise have been vital to getting us to this point. As we move forward, I encourage all members to stay engaged and play their part in shaping the future of our Institution.
Matt Garside, 140th IMechE President
For more information on the progress of the HQ Programme, visit imeche. org/hqprogramme/login

The increasing prevalence of autonomous vehicles will unlock efficiencies in some areas and throw up engineering headaches in others, writes Chris Stokel-Walker
Fleets of self-driving vehicles are coming to the world’s roads. Whether it’s in Phoenix, Arizona, where electric taxis glide to and from their Waymo depot to recharge, or on the streets of the UK following a government decision to bring forward trials, the future is now inevitable.
Waymo provides a vision of what could be around the corner. The firm says its US-based fleet provided 4 million driverless rides last year, cutting 6 million kilograms of carbon dioxide from the air. It was able to achieve this by working its vehicles at a rate humans could never match.
The company’s vehicles spend up to 20 hours a day in service – a rate unimaginable for privately owned cars, not least because human drivers would fatigue long before that. The workload rewards the simplicity and low maintenance of electric drivetrains, but it also requires redefining what a powertrain is when a car never sleeps.
Electric revolution
“The advent of autonomous vehicles marks a significant shift in the automotive industry, promising to revolutionise how we perceive and interact with transportation,” says Otmar Scharrer, senior vice president for R&D e-mobility at ZF Group, a German company that develops vehicle systems. But the always-on nature of how those vehicles work puts pressure on powertrains, he says.
“Autonomous vehicles, designed to operate continuously, demand highly reliable and efficient powertrains,” he says. That means they are likely to run out of steam quicker and be prone to earlier faults than those in traditional vehicles, which are used less frequently and for shorter periods.
“These vehicles will likely require advanced driveline technologies that
integrate seamlessly with braking and motion control systems to ensure optimal performance and safety,” Scharrer says. “The need for continuous operation will drive the development of powertrains that can withstand prolonged use without compromising efficiency.”
Drivetrain durability is one problem. Another is keeping vehicles charged on the road. Slow charging is topped
‘The advent of autonomous vehicles marks a significant shift in the automotive industry’
up with fast charging, but that pace abuses cells so developers are programming vehicles to preheat on the way back to base, pushing cell temperatures upwards so they last longer, extending life by 15% in early trials. The alternative is to simply swap batteries. California start-up Ample robot-swaps a depleted pack for a fresh one in five minutes.
It’s not just vehicles ferrying humans that could benefit from these redesigned, always-on powertrains. Amazon (and subsidiary arm Zoox), FedEx, UPS, DHL and Walmart are
Autonomous electric vehicles like the fifth-generation Waymo Driver on the Jaguar I-Pace are a common sight in Phoenix
all big logistics firms investing in autonomous delivery and trucking.
The problem with driverless vehicles is that you have no human available to understand or fix faults. To solve that problem, Volvo Autonomous Solutions operates duplicated steering actuators, power supplies and sensor fusion computers so the truck can continue or reach a safe stopping spot after a fault.
Beyond catastrophic failure, there is also an engineering quandary in that parts wear out quicker – including the batteries powering the next generation of electric cars. Tesla’s own data shows a noticeable capacity loss after 200,000 miles in their vehicles.
Potential solutions to those issues include predictive maintenance, such as vehicles leaving the depot through a scanner that can flag issues, which early research suggests could improve vehicle availability by around 20%.
The Powertrain Systems for a Sustainable Future Conference 2025 will take place at the British Motor Museum near Warwick from 21-22 October. Find out more and sign up at imeche.org/events

The rise of new technology is transforming engineering and reducing the risk of costly mistakes, writes Chris Stokel-Walker
The old mantra ‘check twice, cut once’ is a vital reminder when making anything – and engineers know more than most about the risks of costly mistakes. While physical prototypes are always useful, the rise of technology enables engineers to simulate and model ideas before putting hard cash into building things.
AI is poised to play a “huge role” in the future of simulation platforms, particularly in creating high-fidelity digital twins that mirror the real world, says Saber Fallah, professor of safe AI and autonomy at the University of Surrey. These digital twins – physical infrastructure or products recreated in silico, where they can be tested with a number of variables – can help optimise and validate assumptions, improving designs in the long run.
“The value of these AI systems is the generation of high-fidelity simulation platforms,” says Fallah. “These models have access to the different types of data – for example, images, LiDAR, canvases, all these things – so they can produce more realistic environments based on data and generate different sorts of environments.”
It’s not just in the ability to produce these simulations that AI has proven transformational. It also makes it easier to spin up simulations without coding expertise. Traditionally, harnessing the power of those data streams and producing high-fidelity simulations would require high-level knowledge of how to develop such models and code them by hand.
With “classical models or physicsbased models, it was really hard to generate a multi-purpose or generalpurpose simulation platform,” says

Fallah. However, large language model-based platforms can turn plain text queries into complicated simulations in an instant – and troubleshoot any errors that arise.
Digital twins have become a buzzphrase within engineering, perceived as a solution to many issues faced by a sector with high overheads and constrained investment. A 2024 survey of industry found that around two-thirds of businesses say the main reason for using digital twins is to optimise processes to be more efficient, while six in 10 say they help support decision making.
One area for more growth is in design and development, with only 40% of respondents saying they
Two-thirds of businesses that use digital twins do so to optimise processes to be more efficient
use twins for that. The team behind the survey, representing several universities worldwide, say digital twins “are gaining popularity in both academic and industrial contexts”.
Beyond catalysing new ideas, the supercharging of simulation also reinforces the ability to fine-tune preexisting designs. Take the design and testing of vehicle safety features, such as crumple zones, roll bars or other areas. “Using reinforcement learning, we can train simulations or agents of
the simulation to create cases that rarely happen in the real world,” says Fallah. That allows manufacturers to test the impact of one-off crashes in silico, rather than in real life.
It’s a principle Fallah and his lab tested themselves with Jaguar Land Rover, designing specific agents using reinforcement learning to maximise the chance of accidents with autonomous vehicles to check the safety of the technology.
But it’s not just worst-case scenarios modelling benefits. For transport infrastructure on roads, rail and in the air, simulation can understand population-level flows. “We can use AI-based simulations to optimise traffic for managing fleets,” he says. “We can also look at public transport network systems and logistics, ondemand and mobility models.”
Fallah can envisage a future where governments and testing bodies could adopt simulation and modelling tech to develop policy and approve infrastructure – though issues inherent within AI will have to be ironed out before that occurs, particularly in sensitive areas such as healthcare. “I believe AI and large language models will play a significant role in the next generation of simulation platforms, which maximise their productivity in the real world,” he says, “and provide near-real world performance.”
Simulation and Modelling 2025 will take place in Birmingham from 30 September to 1 October, covering the latest applications of simulation technologies, AI and machine learning, digital twins, multiphysics modelling and much more. Register at imeche.org/events
ll relationships are based on communication – and the more effective that communication is, the more successful you can be in both your professional and personal lives. If you want to improve your communication skills and get better at influencing people, an upcoming IMechE training course could be for you. Communication and Influencing Skills uses well-established models and theories to highlight the skills, knowledge and behaviours you need, using them as the foundation for an interactive and engaging workshop. Phill Slater is one of the course trainers. Here he gives five useful tips to start communicating with and influencing people effectively.
Understand the power of effective communication
Effective communication is the foundation for building relationships based on trust, respect and mutual understanding. Never underestimate its value for achieving long-term success. If it’s not there, it doesn’t mean you can’t have success, but attaining it will be harder and not as sustainable.
Make sure you look and sound like you are completely there in any conversation. This means more than being in the room – pay attention to your words, body language and tone. Keep your words concise, your body language open and welcoming, and your tone even and measured.
If you’re not able to be present in a particular moment, it is often better to delay a conversation than to attempt one when you are not able to focus.
Adapt and connect
A 02 01 03 04 05
Listen to how other people communicate with you. This is likely to be their preference,

particularly when under pressure. For example, some people are comfortable with ambiguity, while others like to be provided with more detail. Try mirroring their style to deepen the connection and build engagement.
Understand your personal power
When seeking to influence or persuade people, a range of powers are available to you. Depending on the situation and who you are seeking to persuade, choosing the right powers and deploying them effectively could be the catalyst for success.
If you are an engineer working on a project, you might need to influence a key stakeholder to support a decision. In that situation, your powers might be as simple as basic people skills, but they can also include your expertise – you might be the only person who understands how to use a piece of software, or a piece of machinery, and you can point back to previous experiences where you have been successful. That gives you credibility, and credibility gives you power.
Choosing the right persuasion powers and deploying them effectively could be the catalyst for success
Be assertive – but not pushy Assertiveness is about balance. It’s about being forthright with your wants and needs, while still considering the wants and needs of others.
When you are being assertive you are self-assured, and you can draw power from this to get your point across firmly, fairly and with empathy. It is a vital tool for your communication toolkit when preparing for and having those critical conversations. Practice makes perfect.
IMechE’s Communication and Influencing Skills course runs in London from 6-7 October and Manchester from 12-13 November. Find out more and book at imeche.org/training-qualifications
New IMechE president Matt Garside wants to build trust in engineering – both within the Institution and beyond
By Professional Engineering
When he was a child, Matt Garside got a firsthand look at just how far a career in engineering can take you. His father –also a chartered engineer – worked all over the world on projects, and Garside spent time in both Saudi Arabia and India growing up.
Back in the UK, he vividly remembers the moment his father got his chartered engineer status and the proud moment when the certificate went up on the wall. So, when Garside was able to join IMechE as an affiliate member while studying at De Montfort University in 1999, he jumped at the chance.
He has spent time at virtually every level of the Institution since then, starting with rejuvenating and chairing the Leicester Young Members Panel, and ending with stints on the Trustee Board and as an elected Member of Council. He even met his wife through IMechE.
In parallel, Garside has built a successful career in industry with roles at Alstec, Rolls-Royce, Babcock, Assystem, Nuvia, AWE and Costain, among others. In a wide-ranging conversation with Professional Engineering, Garside spoke about his goals for his year as president, and the importance of trust to IMechE and the engineering profession at large.
What are your goals for your IMechE presidency? Everything hinges around trust and trying to celebrate the trust that engineers have within society. Ipsos do an annual survey where they ask about 1,000 people to rank different professions and, since engineering was added to the list in 2018, we’ve been in the top six of about 25 or 30 professions. Last year, we were in the top two – we’re rubbing shoulders with doctors, nurses and other people you would want to trust. But when you look internally at IMechE, maybe that level of trust between the Trustee Board and the Council is a challenge, based on some of the past decisions that have been made, but


‘My approach is very much collaborative, making sure we’re all trying to do the best with the team we’ve got’
IT IS Lighter, IT IS Smaller: IT IS a Wave Spring
RotorClipWaveSpringsareengineered to save spaceandweightbyreducingspringheightsup to 50%.Ourexperiencedengineeringteamis readyto assistyouinspecifying a standard springordeveloping a customdesigninthe materialandsizeyourequire.Fromprototype to production,we'llprovideyouwiththe perfectspringsolutionforyourapplication.
°':~[!] DREAM IT@ DESIGN IT

Max Buili:I Volume 600 x 600 x 1300 mm
Part Size from 1.0mm up to 1.3metres
Layer height from 20 microns
Materials include:

‘We need to try to improve our values and behaviours, and make sure we create that safe space for people to work and collaborate in’
there’s not the focus on the reallygood decisions. My approach isverymuch collaborative, making surewe’re all trying to do the bestwith the teamwe’ve got.There’s also the memberproposition that I’m keen to push and promote.We need to remain relevant to ourmembers.
How can IMechE stay relevant for members?
I think part of it is making surewe’ve got something for everybody. In the past, I’vevolunteered forarmed forces charities andwe have a numberof peoplewho are in the armed forces, and the armed forces have been proactive in incentivising people to join us as a chartered or incorporated engineer.Theirtransitionwhen theycome out into civilian life can be quite a stark, difficult, lonely place to be. Iwant to make surewe’ve got something thatwill offerthem some assistance.We do have the Support Network that has some elements on the advice side, but actuallyit’s about understandingwhat it is ourveteranswant from an institution like ours.
We also need to be engaging theyoung members. They’re the next generation.We have a strongYoung
Members Board at this point in time, andwe’reworking on President’s Champions, a scheme thatwill take young memberswho are not fullydeveloped and give them some opportunities to access people like myself, people on theTrustee Board, people on the Council or in otherboards and committees to develop and become better, more rounded engineers.
There’s also the long-running question of what will happen to the IMechE building at One Birdcage Walk. I dare sayyou’ve talked to the last fewpresidents about this, and I had quite a pointed question during my president’s address aboutwhat’s going to happenwith the building. I haven’t committed to making a decision because I’ve seen so manyotherprevious presidents going through this. Mystatement is:we’ll make significant progress.We need to make surewewalk into the decisionwith eyes open and understand the risks associatedwith each option. I think it comes down to headversus heart. I have an attachment to the building because I’ve been using it forthe last 18years orso, but ultimatelywe’ve got to dowhat’s best forthe Institution.
What other key challenges facing IMechE will you try to get to grips with over the year?
We need to tryto improve ourvalues and behaviours, and make surewe create that safe space forpeople to work and collaborate in.We are developing avolunteer code of conduct thatwe can hopefullyroll out and get people to agree to and abide by.
What are you most looking forward to over the course of the next year?
Attending the Challenges is a majorthing forme to see howwe are engagingwith theyoung members and potential futureyoung members and developing engineers.There’ll also be opportunities to interface with otherinstitutions.We’re hoping to be a lot more outward-facing and lift the lid a little bit on the inner workings of IMechE.And the international trip at the moment is looking like the Oceania region, so I’m looking forward to engagingwith as manymembers as I can as I move through theyear.
What will success look like when you hand over the reins in a year’s time?
In an idealworld,wewould have made a decision on the HQ and a successful pilot of the President’s Champions initiative –we’ve got to get the business plan sorted and approved, and then do itwith a small group of people to find outwhatworks andwhat doesn’twork.And then making surewe remain inclusive, so looking forward to getting the updated strategyfrom the culture and inclusion committee on the next step.
It’s been 200 years since the first fare-paying passenger journey on the railways. As IMechE marks the milestone with a Year of Rail, we ask: will we recognise the network two centuries from now?
By Chris Stokel-Walker
Atransport revolution took place in 1825. Britain took fare-paying passengers for 26 miles along the world’s first steam-powered public railway. Tests had been going on for two decades before that, ever since Richard Trevithick’s Penydarren steam locomotive proved steam power could haul loads across nearly 10 miles of track in Wales. But it was George Stephenson’s locomotive pulling passengers from Shildon to Stockton that kickstarted the shift.
An industry was born that has survived centuries of change and helped connect us all. Two centuries on, railways have transformed our society, the economy and travel.
That was then, and this is now. On the 200th anniversary of that first passenger journey, we’re asking what the railway might look like in 2125 or 2225 – and how engineers are laying the track for that future.
Professor Clive Roberts, executive dean in the faculty of science at Durham University and previously visiting professor of railway systems at the University of Birmingham, thinks the biggest visible future change in passengers’ lifetimes will be invisible to the untrained eye. Autocoupling may be a small tweak, but it could have a significant impact on rail.
“Those sorts of things create convoys,” he says. Some realism is
also needed when forecasting the future of rail. “The key point is we’re not going to be able to change the laws of physics,” Roberts says, arguing that strings of digitally linked trains running seconds apart, rather than faster top speeds, will unlock huge gains in capacity and punctuality –both of which are bugbears for the current generation of rail passengers.
Living within limits
Roberts’ point about physics matters.
A steel wheel on a steel rail still offers the lowest rolling resistance of any mass-transit mode, but lateral forces, braking distances and signalling headways impose hard ceilings on throughput. The industry’s answer is to compress the gaps between trains using real-time positioning, automatic couplers and moving-block signalling.
“That’s about better acceleration [and] capacity,” he says, warning that shiny, new vacuum-tube concepts receive what could be considered undue “emphasis”, while the humdrum task of squeezing more trains on to the existing network is the bigger prize.
That’s less a hardware engineering problem and more a software engineering one. After two centuries, the balance of innovation is shifting from physical stuff to bits and bytes. Sensors stitched into bogies, axles and switches can feed machine-learning algorithms that spot faults before they stop trains. Control systems that used to be tied to fixed-block signals can now follow individual vehicles, giving better visibility over how the system is running. And beyond the tracks, journey planners exploit live occupancy data to nudge passengers on to off-peak trains or alternative routes.
A cleaner, greener railway?
Digital control could help smooth out the rush-hour crushes and delays that blight the rail network. But work elsewhere can also make it cleaner. Stuart Hillmansen, professor of railway traction systems at the University of Birmingham, frames this as another great propulsion transition. “Originally, rail vehicles were pushed by people. Then horses were used, and then steam, and then
‘Originally, rail vehicles were pushed by people. Then horses were used, and then steam, and then diesel and electric’

diesel and electric,” he says, noting that truly disruptive shifts have been rare. The current shift is away from carbon.
Battery trains are being adopted, albeit very slowly, in the UK at present. In November 2023, LNER ordered a fleet of tri-mode intercity trains. In November 2024, Hitachi Rail replaced the diesel engine in one of its intercity Class 802 trains entirely with a single 700kW battery. Following the successful test, which saw the train run on battery power alone for 70km, Jim Brewin, chief director of Hitachi Rail UK and Ireland, said: “Everyone should be immensely proud of creating battery technology that had zero failures during the entire trial. Using our global expertise, Hitachi Rail has created new technology, which means the greenest mode of transport just got greener.”
Hitachi followed Great Western Railway, which set a UK record for the longest distance travelled on battery power alone – 138km – in February 2024.
Initial investment
Others aren’t quite so gung ho about the potential of batteries as Brewin. “I’m slightly sceptical, but people I talk to are very confident about it,” says Christian Wolmar, a rail industry expert. “Electric trains have been around for more than 100 years, and are clearly a more efficient way of doing things. But they require initial investment. It’s particularly difficult at the moment because there are so many stakeholders.”
Evidence for what UK railways could look like in the future can be seen elsewhere. Japan Rail’s fleet of 18 Dencha trains were converted from diesel to battery power between 2016 and 2019, in turn becoming the world’s first fully electric fleet. The model converts AC power it takes from overhead lines to charge on-board batteries.
Hydrogen fuel stock demonstrations such as HydroFlex, which began in 2018 by converting a Class 319 train to run on gas and battery power, and which has managed to surmount Lickey Hill, the steepest mainline
incline in the UK, show that on-board fuel cells can extend range without the weight penalty of giant battery packs that Wolmar is worried about. All of which adds up to the potential decarbonisation of the network. But the timespan for that is less certain. “Over the next 20 to 30 years, we’ll see the move to decarbonise rail, and then in 100 years’ time, people will have fond memories of diesels,” Hillmansen predicts. He sees diesel locomotives surviving only on heritage lines, much as preserved steam engines do today.
Roberts is open-minded about alternative fuels, pointing to ammonia as one fuel source, but believes overhead and third-rail wires will still do most of the heavy lifting. “Electrification will continue wherever it’s appropriate,” he says. Putting up those wires is capitalintensive, as the stark stat that the UK network remains stuck at around 38% levels of electrification shows, but that investment can pay off in the long run. Electric trains cost less to run, accelerate harder and last longer.
Finding alternative ways to power locomotives is one of the key areas of engineering innovation, but mass matters on railways too. Take out a tonne from every coach and you can save energy, brake wear and track damage over decades. Roberts expects breakthroughs in “lightweight and perhaps self-healing materials” to migrate from aerospace and automotive into rolling stock.
Advanced alloys that autonomously repair micro-cracks and fibre-reinforced composites that match steel’s strength at half its weight could appear first in frames and door mechanisms before spreading to car bodies, he reckons. Meanwhile, additive manufacturing, including 3D printing, is already creating custom brackets and ducting, cutting lead times for spares from months to hours. Combine that with condition-based maintenance and 200 years down the line, depots may stock fewer parts, needing to order replacements only when digital twins predict failure.
‘Electric trains have been around for more than 100 years, and are clearly a more efficient way of doing things. But it’s difficult at the moment because there are so many stakeholders’
The
rail sector has undergone significant changes since 1825. Here are the major stopping points along the route

STOCKTON & DARLINGTON RAILWAY George Stephenson’s Locomotion No. 1 hauls the first fare-paying passengers 26 miles, launching the railway era.
LIVERPOOL & MANCHESTER RAILWAY
World’s first intercity, steamonly line introduces timetables, double track and signalling, proving rail’s commercial power.
George Stephenson’s steam locomotive, pictured below at the National Railway Museum, had a top speed of 15mph

But the future is not all techno utopia. While the sector can work hard on improving locomotives and carriages, there is also the track to think about. On mixed-traffic routes, new freight paths and commuter services compete for the same scarce rail lines. The ability to sustain high-speed rail is in part why HS1 and HS2 have struggled to gain ground in the UK. And, while the Shinkansen in Japan regularly tops 200mph, Roberts doubts headline speeds in the UK will get beyond that plateau because energy use rises with the square of velocity.
“Steel wheels on steel track has got an awful lot to beat,” he says, especially when compared with “concrete and tarmac and rubber
tyres” or maglev exotica. His verdict on Hyperloop, the capsule-based transportation system that hopes to ferry passengers in low-pressure tubes that ride on a thin layer of air and are powered by magnetic levitation (or maglev) batteries, is guarded scepticism. Evacuating tubes raises costs and risk while serving only a sliver of intercity demand.
Hillmansen is equally wary. “There’s been loads of things like this,” he says, but new transport modes find it difficult to gain ground “when you’re up against something that’s established,” crediting high-speed rail with being “quite a good, established technology” that Hyperloop would have to beat on cost, safety and land-take.
Where both academics see genuine competition is on medium-distance corridors, which could jeopardise rail’s popularity. The competition doesn’t come from the likes of Hyperloop, but self-driving vehicles. “There will be some real significant competition to rail from autonomous cars and all those sorts of things,” Roberts warns.
Autonomous taxis, which the government says could be on the UK’s roads by 2027, could erode rail’s 50- to 150-mile commuter demand by offering door-to-door convenience without the parking pain. But Hillmansen is less bullish on that.
“You always get more bang for your buck in the rail system because it’s less: less land, less energy,” he says, hinting that policies on road pricing and carbon taxes could tip the scales.
All the technology in the world is moot if passengers can’t figure out how to get affordable fares. Hillmansen calls Britain’s current ticketing “enormous” in cost and complexity. “I’d like to see big, big improvements, making that more accessible than it is today,” he says, arguing for friction-free, dynamic pricing modelled on mobile data tariffs.
Great British Railways – assuming that it survives its early years and any changes of government over the next decades – plans pay-as-you-go
186319231963 1830189019481976
METROPOLITAN RAILWAY
London opens the world’s first underground passenger line, easing street congestion and inventing the metro.
CITY & SOUTH LONDON RAILWAY
Deep-level “tube” tunnels debut with electric traction, setting the template for modern subways worldwide.
THE ‘BIG FOUR’
The Railways Act 1921 merges 120 companies into Great Western Railway (GWR), London, Midland & Scottish (LMS), London North Eastern Railway (LNER) and Southern Railway (SR), ushering in a new era of regional giants.
BRITISH RAILWAYS
Post-war nationalisation unifies track and trains under state control to rebuild and modernise the network.
BEECHING REPORT
Cost-cutting axe removes 5,000 route-miles and 2,363 stations, reshaping Britain’s rail map.
INTERCITY 125 Sleek, diesel High Speed Train starts 125mph service from London to Bristol, reviving public enthusiasm for rail.
capping across the network, backed by a central database that treats every operator as one railway.
Roberts sees customer-centric thinking translating into personalised journey offers. Your phone might ask whetheryou value time, seat comfort or carbon savings most, chaining rail with shared e-bikes or autonomous pods at either end. Gone, he hopes, is the “one-size-fitsall approach to journey planning” that today forces travellers to pick from a small handful of fares.
Organising for innovation
Hillmansen worries organisational silos are limiting the UK’s ability to test new ideas. While he admits to not being an expert on policy, he thinks the centralisation of control of the rail network could be a boon. “If you keep everything in one organisation, you can be more innovative,” he says. Fragmentation, he continues, burdens inventors with interface contracts and safety cases that deter experimentation.
Roberts cautions that the skills pipeline must broaden. Data scientists, cyber-security specialists and AI ethicists now rub shoulders with traditional mechanical and civil engineers. Railway schools within universities are rewriting syllabuses to reflect that change: modules on power electronics, hydrogen chemistry and resilience

‘People aren’t fearful of travelling by train. The chances of catastrophic collisions are as close as we can get to zero’
analytics sit alongside rail-specific law and economics.
If you ask passengers why they still board trains, safety and convenience top the list. Hillmansen insists the industry must guard that reputation. “People aren’t fearful of travelling by train. The chances of catastrophic collisions are as close as we can get to zero,” he explains, warning that one high-profile automated train crash could chill support for the very digital tools meant to boost capacity. Scenariotesting AI therefore should be scrutinised with the same lens that investigates physical failures today.
CHANNEL TUNNEL
50km under-sea link opens, connecting UK rails to Europe and slashing London-Paris journey times.
HIGH SPEED 1
Britain’s first purpose-built 300km/h line completes from St Pancras to the Channel Tunnel, cutting down crossChannel trips.
ELIZABETH LINE
Crossrail’s 100km east–west artery opens, the biggest single boost to London’s rail capacity in history.
A familiar yet smarter network
Transport Trevithick or Stephenson forward 200 years in a time machine and – provided you booked them a paper ticket, rather than an e-ticket –theywould likely understand how to navigate the UK’s rail system… even if they might wonderwhere the voice telling them “See it. Say it. Sorted” was coming from.
But would we recognise the railway in 2225 if we last that long? Hillmansen thinks so. “My gut feeling is it will not look suddenly different,” he says. The same tracks and trains could endure because theywork. Driverless cars may put a dent in ridership and synthetic fuels may stall electrification. Climate change could redraw the old coastal lines, particularly on the east coast and along the Welsh border. But the basic premise of the rail network would remain.
Trevithick and Stephenson’s innovations highlighted how breakthroughs often hide in plain sight until someone stitches them together to create something novel. Whether the next leap is a convoy of auto-coupled, battery-powered carriages carrying commuters through Birmingham at 30-second intervals, or a hydrogen express cresting the Highlands without a wire in sight, the railway remains a work in progress.
HIGH SPEED 2
Britain’s largest infrastructure project since Victorian times digs north-south high-speed foundations, aiming for a 2030s launch.
IMechE is making 2025 a Year of Rail – a year-long celebration showcasing the expertise and contributions of railway engineers past and present. Through events, training courses and thought leadership, we’re championing the critical role of engineering in shaping the railways of tomorrow. Find out more at imeche.org/year-of-rail
MSc -1 year full time
MSc -2 or 3 year part time
PG Diploma • PG Certificate
Short Courses for CPD

Choose from a selection of 19 course units, delivered by the Consortium members

These five products and projects from the 2025 Paris Air Show could shape the future of aviation, orbit and regional mobility
By Joseph Flaig
Visitors to the 2023 Paris Air Show lived in a different world. Net zero goals were two years further away, tariffs were merely a campaign buzzword and postpandemic recovery was one of the main topics of the day.
External factors were impossible to ignore at this year’s edition of the biennial event, held at Le Bourget Airport in the north-east of the city from 16-22 June. Israel’s ongoing conflicts, the evolving war in Ukraine and Russia, and the shifting geopolitical landscape brought a predictable focus on military technology, with 45% of the show reportedly dedicated to defence and security – a significant increase on previous years.
The exhibition and air show was also overshadowed by the Air India Flight 171 disaster, which prompted Boeing, the manufacturer of the crashed 787, to scale back its involvement. European competitor Airbus therefore hogged the commercial attention, securing orders worth more than $21bn.
Wider access to orbit and rocket reusability were prominent topics at the event’s Paris Space Hub, while the conference halls and stands on the baking asphalt were stuffed with every type of next-generation drone, zero-emission aircraft and eVTOL (electric vertical take-off and landing) aircraft imaginable.
Here are five of the most cuttingedge products and projects we saw at the show.
Vaeridion hopes its Microliner, which uses distributed propulsion, will be ‘the world’s first electric commercial aircraft’

Vaeridion Microliner makes engine failure a ‘minor event’ Distributed electric propulsion has been a common sight on prototypes at recent air shows, with multiple independently powered motors lining the wings of electric planes and eVTOLs.
Munich company Vaeridion is also pursuing a multi-engine approach for its Microliner, which it hopes will be the “world’s first electric commercial aircraft” – but those engines will power just one propeller.
The approach is designed to maximise both redundancy and efficiency, said chief technology officer Markus Kochs-Kämper at the company’s stand. “If we lose one engine, we have no asymmetry, we have no yaw moment. That means the

pilot will hardly realise,” he said. “It gets about maybe 20-30% reduction [in power], maybe 40%, but still enough to hold the climb rate… so this is the first time when an engine failure becomes a minor event.”
Combined with off-the-shelf sourcing of components, the team hopes that the nine-seater’s first flight in December 2027 will be a certifiable design for the European Union Aviation Safety Agency (Easa), shortening the route to commercial deployment.
Another selling point is the decision to house the batteries in the wings, said Kochs-Kämper, similar to the way aviation fuel is stored in conventional aeroplanes. “If you have the batteries in the belly or in the fuselage, and you have a gear-up
‘If we lose one engine, we have no asymmetry, we have no yaw moment. That means the pilot will hardly realise’
landing, you have crash-worthiness issues,” he said.
Cylindrical cells will be combined with a bespoke battery management system and high-temperature packaging, being developed by a head of R&D with space sector experience.
The Microliner is designed for a range of 400km (250 miles), with reserves for an 80km (50-mile) diversion and 30 minutes of loitering. The company’s vision saw it secure an order for 10 aircraft from Belgian business jet operator ASL Airlines at the event.
“What they see within their current business model is that they’re getting stricter and stricter regulations from the airports – what they can fly and when they can fly,” said Vaeridion chief commercial officer Taco Stouten.
“If you look at the airport regulations, all the slots and all the restrictions… it is based on those two factors – how much noise do you make as an aircraft, and how much do you pollute? Well, we pollute zero and our noise is – for an aircraft this size – eight times lower.”


HyPrSpace targets affordable space access with ‘Baguette’ tech “Until a very few years ago in the space industry, the idea was: ‘If it works, we don’t change anything’,” said Sylvain Bataillard, co-founder and chief strategy officer at HyPrSpace. “Then arrived the idea of New Space.”
This triggered an interest in the possibilities of hybrid rocket propulsion for cheaper launch, he told ProfessionalEngineering in the Paris Space Hub hall. Practically all rocket engines run on either solid or liquid propulsion – “extremely mature technologies developed during the Cold War, or even before, on unlimited funds,” as Bataillard put it.
The two approaches have their own advantages and drawbacks, he continued. “Solid is cheap and simple to use, but pyrotechnical, and you can’t modulate thrust. At the opposite end, you’ve got liquid propulsion, with which you can modulate thrust – it’s really effective. However, it’s extremely complicated due to turbo pumps, and it’s extremely expensive.”

Historically the preserve of research students, hybrid propulsion offers a potential middle ground, being explored by the Bordeaux company. Liquid oxidiser is stored in a tank and injected into a combustion chamber containing the solid fuel –recycled high-density polyethylene in this case.
“This technology has the advantages of both,” Bataillard said.
‘This technology has the advantages of both liquid and solid propulsion. It’s simple, it’s cheap – no turbo pumps – but you can modulate thrust’
Durability was a major focus for engine manufacturers in June.
The week before the event, Rolls-Royce launched a ‘durability enhancement package’ aimed at doubling the time on wing for the Trent 1000, extending the time the engines can remain in service before needing scheduled maintenance.
At the event itself, US manufacturer Pratt & Whitney announced a similar package for its GTF engine, which powers some Airbus A320neo planes.
Known as Hot Section Plus, the upgrade package includes 35 parts and is designed to be installed during maintenance visits, starting next year. Enhancements in the high-pressure turbine include an advanced airfoil design with improved coatings. The turbine and combustor also feature an optimised cooling hole size, shape and location, with holedrilling techniques aimed at reducing oxidation.

“It’s simple, it’s cheap – no turbo pumps – but you can modulate thrust and turn the engine on and off. It’s non-pyrotechnical. So on paper, it’s perfect – but it’s not used currently because it suffers from a technological barrier.”
That barrier limits stable fuel mixing and efficiency as engine size increases. HyPrSpace hopes to break through it with a new architecture,
which surrounds a cylindrical oxidiser tank with a very thin toroidal combustion chamber, the walls of which are lined with the solid fuel itself. The liquid fuel is injected into the space between the walls of solid fuel.
“Whatever the size of the engine… the space between fuel blocks is a variable we can choose,” Bataillard said. “The flame is mechanically forced to be really close to the fuel, which brings enough heat to vaporise the fuel, to create enough propulsive material.”
The approach should also ensure proper mixing of the liquid and solid fuels, he added, and minimise the amount that is unused.
The firm has embraced not only the design ethos of New Space, but also its tongue-in-cheek naming conventions. The suborbital Baguette One is planned to launch for the first time next year, followed by the Orbital Baguette One (OB1) microlauncher in 2027. Standing at 17 metres (55ft), the OB1 is designed to launch payloads of up to 250kg (550lb) into low Earth orbit.
HyPrSpace hopes its relatively simple, turbo pump-free design could make space more affordable and enable access for more customers –an alternative to SpaceX dominance.

Artificial intelligence (AI) is now in “all and every function” of Airbus, said Catherine Jestin (above), executive vice-president for digital, during a talk at the show’s innovation-focused Paris Air Lab.
As well as using AI to generate designs, eliminate defects and optimise inventory in production, the European aerospace giant also offers its customers several tools, including the Skywise aviation data platform, which Jestin said is saving clients a total of $200m per year by collecting and analysing in-flight and engineering data.


In five to 10 years, she continued, AI will be “almost everywhere in the product”. This will include providing pilots with additional information and computer vision assistance during difficult landings, she suggested, as well as widespread use of AI assistants.
While Jestin predicted a bright future for the technologies, she warned engineers and other aerospace workers to “make AI one of their best friends”.
“AI will not take your job – but somebody knowing AI will,” she said. “If you want to be in the race tomorrow, you will have to really make AI one of your best friends and be comfortable with it.”
Horizon Aircraft eyes hybrid eVTOL opportunity Hype for eVTOLs, often known as flying taxis, has waxed and waned over the last decade. New designs and prototypes generate huge excitement before the reality of testing, certification and regulation sets in, dragging out projects and pushing commercial flight further and further back.
The hype train was in full force at this year’s event, however, with companies such as ArcherAviation and EHang showcasing their aircraft, and Eve Air Mobility securing an order for 54 units. Those firms, like most in the field, are pure electric. But Canadian start-up Horizon is taking a different approach, which it hopes could secure a decent chunk of the market.
“We saw a decent gap in the marketplace opening up for a longer-range, allweather, faster machine that could carry more and had several other layers of safety and redundancy on board,” said CEO and co-founder Brandon Robinson (above). “We

thought it was smart to have a power source on board that is 30 to 40 times as dense as even the best aerospace-grade batteries.”


For the Cavorite X7, that power source will be jet fuel or potentially sustainable aviation fuel in future. With 800km (500 miles) forecast range and a maximum speed of 450km/h (280mph), the six-passenger, one-pilot aircraft could fly much further than pure electric eVTOLs and much faster than helicopters. The hybrid approach is not the only
‘We saw a decent gap in the marketplace opening up for a longer-range, all-weather, faster machine that could carry more and had layers of safety and redundancy on board’

unusual feature of the X7 – unlike other flying taxis it has fixed wings, lined with battery-powered ducted fans. These will be uncovered for electrically powered ascent and descent before the aircraft switches to a fossil-fuelled rear propeller for horizontal flight, and the ducted fans are covered by sliding panels.
Stressing a “very operational and engineering-focused background”, Robinson said the company was wary of the challenges and strict manufacturing tolerances involved with tilt rotors, tilt wing mechanisms and open rotors.
“We wanted the simplest possible way to transition from hover to forward flight,” he said. The approach avoids significant aerodynamics challenges from variable pitch articulating mechanisms, he added, with a half-scale prototype already demonstrating successful transitions between hovering and horizontal flight.
The X7’s performance advantages could draw attention in the next eVTOL hype cycle – but it remains to be seen if they will be significant enough for customers to overlook ongoing fossil fuel consumption.
Visit imeche.org/news and sign up for the Professional Engineeringnewsletter to stay up to date on the latest aerospace news
HEAVY DUTY Linear Motion Systems
Email: sales@euro-bearings.com Tel: 01908 511733 www.euro-bearings.com/ com bi
PlasticINylonICarbonIWax I RubberIPeekIUltemTM
• SLA Stereolithography
• SLS SLS300. Sinterit
• MJP Pro jet 2500+ W IC
• DLP Figure 4
• CJP Pro jet 660 Pro
• BJP Concr3de
• FFF Omni. Fusion
• FFF-HT Funmat Pro 610 HT
For a quotationplease sendyourSTLfile to: replik8@cdg.uk.com 01420556755

Pentagon delivers a full turnkey solution for plastic injection moulding from one site of UK Manufacture.



Pinpoint precision is the order of the day as giant modules are placed together to create the world’s largest nuclear fusion demonstrator. Any mistakes could be a major setback for the promising power source, which puts metrology – the science of measurement – centre stage

By Joseph Flaig
Big numbers get most of the attention at Iter: the 150,000,000ºC temperature the fusion reactor will hit, 10 times hotter than the core of the Sun; the 100,000km of niobium-tin superconducting strands in its magnets, enough to wrap around the equator twice; the 500 megawatts (MW) of fusion power it will generate from 50MW of input heating power.
But for metrology coordinator Beatrice Alix and the rest of team assembling the world’s largest nuclear fusion demonstrator, it is the small numbers that count. The 100 micron

(μm) alignment for interfacing between conductors, for example, or the maximum uncertainty of 0.25mm for the position of components that weigh dozens of tonnes.
Precision is key and the stakes could not be higher. The goal at Iter (which stands for International Thermonuclear Experimental Reactor) is, in the words of chief scientist Alain Becoulet, “creating a Sun here on planet Earth”. If the team succeeds, they could transform global electricity production – but if they fail, it might scupper hopes for our most promising future power source.

First, however, they need to finish building it. Metrology contractor Hexagon invited a group of journalists for a behind-the-scenes tour of the facility in the south of France as the team prepared to add the second of nine key modules to the reactor.
Thick forest leads up to the barbedwire fence of the 180-hectare Iter (pronounced ‘ee-tear’) site, which juts out from the rolling landscape. The rugged brown hills of SaintPaul-lès-Durance, overlooked by the snow-capped Alps in the distance, are covered in scraggly woods of olive, pine and cedar. In early May, the famous Provence lavender is not yet in full bloom.
Entering the security checkpoint, the first thing you notice is the row of flags: China, the EU, India, Japan, South Korea, Russia and the US standing proudly next to each other. This is a collaboration that transcends national disputes in search of practically limitless clean energy.
The international project is a “human adventure”, says communication officer Sabina Griffith. Sitting in the board room (which, with its long oval table, is more than a little reminiscent of the war room in the film Dr Strangelove), she sets out the project’s vision.
“The Sun and the stars, these are our role models. And for decades, centuries, mankind has thought about ways to make this vast energy accessible for us here,” she says. “Down here on Earth, we have to play a lot of tricks.”
Those tricks will take place in the doughnut-shaped tokamak reactor, the largest ever built. The fuel, hydrogen isotopes of deuterium and tritium, will be heated to incredible temperatures inside the reactor, creating a spinning cloud of plasma. That will be contained and compressed by immensely powerful magnets, forcing the positively charged atoms together. When they collide, they will fuse to form heavier helium nuclei, releasing neutrons with vast amounts of energy. Those
will hit the steel walls of the reactor, transferring kinetic energy into heat. Iter will not be the first project to make that happen. Dozens of fusion reactors have been built – West, the world’s first superconducting tokamak, is just next door – and many more are planned. Iter’s distinguishing feature is its incredible size, with a plasma volume five times bigger than previous reactors.
Think of a nightclub, Griffith suggests. There are fewer people on the dancefloor at the start of the night, with slower music. More dancers join in as the DJ increases the tempo and turns up the volume, increasing the chance of collisions. Iter’s enormous scale allows the DJ to blast the tunes as loud as possible. That approach should allow Iter to clear major hurdles, the developers hope. The fusion conditions should be sustained mostly by heat from the fusion reaction, which in turn should release more energy than is put in. Engineers are aiming for a fusion energy gain factor (Q) of 10, meaning

‘The Sun and the stars are our role models. For centuries, mankind has thought about ways to make this vast energy accessible for us here. On Earth, we have to play a lot of tricks’

Iter is located in Saint-Paullès-Durance in the south of France, framed by the Alps
Above: The cavernous space of the assembly hall

it should turn the 50MW of input heating power into 500MW of fusion power. That output will produce hot air and steam, with electricity generation not part of the project. In future power plants, the steam would drive turbines to generate electricity. Those future projects are the reason for Iter, which has been described as the most complicated engineering project in human history.
“This is really a key experimental step between today’s fusion research machines and tomorrow’s fusion power plant,” Alix says. “We are in a very tricky [position] here, trying to achieve this big challenge of building Iter as well as possible.”
Standing outside the assembly hall after a short shuttle from the board room, it is difficult to grasp its true scale. The telltale signs of ascending storeys are absent, the shiny corrugated walls instead punctuated by single vents, pipes or protruding
staircases. There is one revealing measure, however – look towards the roof for a few seconds and your neck will start to hurt.
Walking inside, the scale is still hard to judge. Workers with red and white helmets scuttle around giant scaffolds in the cavernous workshop, where components are cleaned and placed in bespoke lifting tools to be moved and assembled. Here, the nine modules of the doughnut-shaped vacuum vessel are put together on huge ‘sub-assembly’ structures.
Five storeys tall and weighing as much as four fully loaded jumbo jets, the D-shaped modules consist of a core sector structure, thermal panels for insulation and a pair of toroidal field coils, which will confine the plasma particles during operation. In early May, one has recently been placed in the adjacent tokamak pit, while another is being carefully assembled. The central solenoid magnet stands nearby, a tower wrapped in scaffolding, with four
of six modules already stacked on top of each other. When complete, its magnetic field will be so strong it could levitate an aircraft carrier.
Watching the diligent and methodical work going on around the hall, it is easy to forget that the giant components are the first of their kind. Great care is needed to prevent potential issues such as collisions between the vastly expensive parts.
When complete, the reactor will be a bit like a “nuclear Swiss watch”, according to Becoulet. “We need the precision of a Swiss watch but with the size of nuclear activity. So it’s a bit of a paradoxical challenge.”
Tackling that challenge requires a forensic focus on metrology, the science of measurement. At Iter, equipment from Swedish multinational Hexagon includes probing systems and scanning devices for large volumes, as well as handheld scanners for close-up assessments.
The half-assembled vacuum vessel module, currently being worked on by crew members in a cherry picker platform, is covered in small red plates and reflectors, creating an invisible web of hundreds of lines of sight. These enable high-speed dynamic measurements from the Leica Absolute Tracker AT960, which probes, scans and inspects with six degrees of freedom to ensure everything is where it needs to be.
The system uses the Absolute Scanner AS1 for non-contact 3D measurement. A modular design means the scanner can also be used on portable measuring arms without
‘We need the precision of a Swiss watch but with the size of nuclear activity. So it’s a bit of a paradoxical challenge’


realignment, a useful time-saver in such a high-intensity assembly.
The metrology team will also be responsible for risk during the operation and maintenance of the reactor, both of which will create their own hurdles, Alix says.
Components sitting at room temperature will face not only extreme heat but also temperatures of -269ºC from the liquid helium needed to achieve superconductivity in the reactor’s magnets. Those extremes will cause components to deform and change shape, so precise clearances between parts must be set and maintained around the machine.
Fiducial nests
Once modules are ready for assembly, a short crane ride awaits. In a process that can take 36 hours, a ceilingmounted crane lifts the 1,350-tonne parts up, across the assembly hall wall and above the adjacent tokamak pit. They are then gently lowered into the pit, with work pausing whenever

From
Iter travel
its 45 member states; the tokamak pit has a space station feel; precision measurement is the name of the game when building a reactor on this scale
instruments show any swing from the pendulum effect. “There are metrology cameras everywhere,” says Griffith. “Once it’s lowered, it will remain in its almost final position for two or three days, until the metrology team say ‘Go’. It has to be aligned with sub-millimetre precision.”
Standing on a platform looking down into the pit, the tokamak feels like the inside of a space station. Workers busily move around different sections of the 28m wide, 29m tall reactor, which will include more than 1 million parts. Every piece must seamlessly integrate into the whole, regardless of its origin in the supply chain in any of Iter’s 45 member states.
‘None of these components are perfect. Nothing is built exactly to design, and that’s why we need the as-built shape. Anything below 50mm clearance is a warning area’
Red laser reflectors and yellow targets known as ‘fiducial nests’ on surfaces around the giant volume allow the metrology team to reference each component in space while everything is visible and accessible. Key fiducials, which will still be visible after assembly, will provide reference for the final shape of the machine.
Each of the nine sector modules should be in place in 2027. After that, two and a half years of welding will begin, completing the vacuum vessel. A combination of manual and robotic techniques will be used on 40km of passes, with internal metrology tracking any structural changes. Some welding shrinkage is expected so deep scanning will check for affected areas.
Metrology is key for predicting and countering any potential future issues, Alix explains. “None of these components are perfect. Obviously nothing is built exactly to design, and that’s why we need to have the as-built shape,” she says. “Anything that is below 50mm [clearance] is a warning

area for us; there should be spotters to look at those locations. And anything below 10mm clearance is considered as a clash, and mitigation has to be implemented in that case.”
SpatialAnalyzer software from Hexagon enables the Iter team to validate the constructed machine against the original design. Reverse engineering goes hand-in-hand with metrology, with any deformations digitally replicated to highlight areas that might need future attention.
“We require real measurement of as-built components, then do a ‘virtual fitting’ to compare with the CAD files in the hybrid model. This data is then combined with the supplier data,” Alix says. “This set of data helps us to identify any deviations, repairs, clashes, collision rates or potentially not being able to assemble as designed. It saves both cost and time, so it is key to the success of the project.”
Digitalisation of the reactor will also be key for its eventual operation, which should start from 2034.

‘We try to stay out of geopolitical tactics and so on. This is not our turf. It’s a bit like the Olympic Games, you know? We try to focus on the sports, and fusion is our sport’
“The moment we switch on the machine, it should work,” Becoulet stresses. “We are very significantly augmenting our capacity to manage all the knowledge, all the data, all the information we have of all these subsystems… we are embarking on a very ambitious digitalisation of all the facility, the systems and so on, in order to perform efficient operation.”
None of this comes cheap. The project is expected to cost more than €25bn, up from original estimates of €5bn. It is also far from easy and the work has been dogged by repeated delays, with energy-producing reactions not expected until 2039.
If the project is successful, however, it will benefit countries around the world. The international collaboration is remarkable in the midst of external conflict – but, as the Iter team points out, collaboration on tokamak reactors has been ongoing since the frigid depths of the Cold War, when a
delegation of British scientists from the Culham Centre for Fusion Energy visited and validated a Soviet machine in the 1960s.
The Iter project itself was kicked off in earnest by a fireside conversation between US president Ronald Reagan and Soviet Union president Mikhail Gorbachev in 1985, long before the international consortium came together to sign a formal agreement for its construction in 2006.
“With the war going on in Ukraine, we had many discussions in-house and on political levels [of] what to do with our Russian partner,” says Griffith. “The answer is very easy. Russia is and remains a partner of Iter because our goal is to deliver fusion energy. We try to stay out of geopolitical tactics and so on. This is not our turf. It’s a bit like the Olympic Games, you know? We try to focus on the sports, and fusion is our sport.
“It still gives me the goosebumps, sitting in these meetings. To observe these nations that are outside at
war with each other, or have been at war with each other not so long ago. The US, Japan and Europe, and so on. And here we are discussing –openly discussing – a new nuclear technology, a peaceful use of nuclear technology.”
The work at Iter is “apolitical”, Becoulet says. “We don’t need to deal with this. The flags are the flags of our members. If they want to fight against each other, it’s their point, not ours.
“So we refrain from doing any politics inside – which, by the way, I think is the right thing to do. If you don’t like China or the US today, you just quit the project yourself.”
He adds: “We are proud of being an example… we think that science is one of the areas where this diplomacy is extremely important, and maybe very fruitful.”
The UK is one country that will not automatically share that bounty. It left Euratom (the European Atomic Energy Community) and Iter following Brexit, and both the UK and EU have reportedly
Small numbers are in focus during assembly, but Iter’s ambitious goals will be enabled by the giant scale of the finished facility.
1
Including each of the following subsystems, the tokamak will be the world’s largest when complete, weighing 23,000 tonnes and creating a plasma volume of 840m3 .
2
The central solenoid, along with the ‘D’shaped toroidal field magnets and poloidal field system (both in orange), will form the largest superconducting magnet system ever built.

‘This industry is ready to kick in. Here is where the private sector and other new projects are essential, to keep this industry and the knowledge containment alive’




Formed of a base, lower cylinder, upper cylinder and top lid (labelled), the cryostat will be the largest stainless steel high-vacuum pressure chamber ever built, at 16,000m3 .
Weighing more than the Eiffel Tower at 8,000 tonnes, the stainless steel vacuum vessel will house the fusion reactions and act as a first safety barrier.
The divertor will control exhaust of waste gas, including helium ash, from the bottom of the vacuum vessel. Made of 54 10-tonne modules, it will face the highest surface heat loads.
From right: Iter is a truly collaborative effort, uniting teams from China, the EU, India, Japan, South Korea, Russia and the US 3 4 5
snubbed approaches from each other for renewed involvement in the programme. The two are “moving closer”, however, Griffith says in May.
With the Trump administration cutting billions of dollars of science and research funding, there are also fears the US could pull out – but with much of the investment already made, it would likely be the biggest loser from such a move.
Despite the grand scale, the giant price tag and the international significance, Iter is a prototype. But if it can prove the technology works and show how it can provide huge amounts of energy with relatively small amounts of fuel, its developers hope it will be swiftly replicated at utility scale around the world, transforming the fight against climate change in the second half of the century.
The aim is to establish a fusion industry around the world, Griffith
says: “Once we have Iter and Iter says, ‘OK, go’, we can do it. This industry is ready to kick in, we multiply what is learned, we have people that are trained on the job, we don’t have to start all over, again and again. Here is where the private sector and other new projects are essential, to keep this industry and the knowledge containment alive.”
Speaking to employees of Iter and Hexagon, they clearly share an emotional connection to the transcendent possibilities of the project. Contract manager Méhand Idri, who previously worked for the measurement-focused company but now works for Iter, says he is even delaying his retirement by a year because he feels this project is so important for future generations.
There is a long way to go and it remains to be seen if Iter will be successful in its objectives – but, at the moment, it feels like things are moving in the right direction. 2024 was the first year the project delivered on schedule and to budget, and the assembly team aims to accelerate its work over the next two years.
Metrology is a key part of ensuring that Iter can be replicated. “Iter is a one-of-a-kind project,” says Wandrille Vallet, vice-president for new industries at Hexagon Manufacturing Intelligence. “But after that, when you go through to other industries, you need to do it at scale. You need to be able to repeat that.” Ultimately, those tiny measurements and tolerances could end up having a giant impact.
A recent report on the importance of metrology in the engineering industry, entitled ThePower ofPrecision:HowBetter MeasurementDrivesEngineering Excellence, was published jointly by IMechE and the National Physical Laboratory. Download the report at imeche.org/policy-and-press
McMurtry’s hypercar turned the automotive world on its head with tech that may have wider applications



ThomasYates sat in the driver’s seat of the stationarycar. He pressed the accelerator and it slowlyedged forwards forjust seven seconds, travelling roughlyhalf the car’s own length – but the assembled audiencewhooped and cheered.The reason?The carwas upside down.
Theworld-first demo on 10Aprilwas made possible bya proprietaryfan system on the McMurtrySpéirling hypercar, capable of generating 2,000kg of downforce –without anyforward movement.The eye-catching displaywas the latest impressive achievement enabled bythe Downforce-on-Demand system.The Spéirling prototype is the fastest around the Top Gear track, beating an F1 carby3.1 seconds (although bothwere disqualified fornot meeting requirements), and it also holds the record forthe fastest hill climbs at Goodwood Festival of Speed and the Laguna Seca Corkscrew. Now McMurtryis planning to build 100 at its Cotswolds factory– and the tech could havewiderapplications.
“To enterthe automotiveworld as a newbrand,we concluded in about 2018 thatwe needed to produce a smallvehiclethathadtrackperformancebeyondanysort ofconventionalmeasure,”sayscompanydirectorYates, who founded the firmwith the late Sir David McMurtryin 2016. But howto make a smallvehiclewith F1-like performance?
“I’ll just suck it to the ground”was the response from prolific inventor McMurtry.The active downforce techniquewas explored in the Chaparral 2J and the Brabham BT46 F1 carin the 1970s, but subsequentlymothballed.
The system on the all-electric Spéirling works bycreating a partialvacuum in a sealed area underthe car.The force of that lowpressure region acting on the bottom of the chassis surpasses the mass of thevehicle, providing huge amounts of
grip in normal use – and suspending it above the ground when inverted.
Despite successful tests in the run-up to the jawdropping stunt,Yates says he got “verynervous” as theyapproached “the opportunityto destroya hugely valuable and important prototype”.While calculations showed itwas possible, determining the force required to maintain friction at 90ºwas one of the trickyelements. “Ifyou mess it up andyou smash up millions of pounds’ worth of invaluable prototype… then all of a sudden it looks likeyou’ve done averysillything,” he says.
Sitting in the caron the speciallybuilt rotating rig was an incrediblystrange feeling, he adds. “The funny thing is the simple things – likewhenyou flip the rig, suddenlyit’s quite dark underneath it;you’re in bright daylight and then suddenlyyou’re in the shadow.”
On and off track
The upside-down drive is a compelling image, butwhat it reveals is fairlysimple – absurd grip levels, even at low speeds.Thiswas such an important target forthe project because race cars spend most time on a given lap in its slowersections,Yates says. “Ifyou can take something thatwas previously, let’s say, a 60mph cornerandyou can make it a 100mph corner,you have averysignificant improvement in lap time,” he says.
OTHER WEIRD THINGS WE LEARNED WHILE MAKING THIS ISSUE:
Cyborgbeetlescan besteeredwithvideo gamecontrollers(p11) TheMicrolinercraft makesenginefailurea ‘minorevent’(p50)
Iterreactorwillhit temps10timeshotter thanSun’score(p56)
The consistent grip has another unusual effect – drivers reportedly become accustomed to the performance of the carmuch quickerthan invehicles with conventional lineargrip.
Yates sees opportunities to improve vehicles beyond racing applications, and the companyis in discussions to sell the technologyto othercompanies. He is even open to more dramatic demonstrations in future: “If, let’s say, we got a phone call from Monaco and theywanted the tunnel to be driven upside down,we’d be interested in that.”

